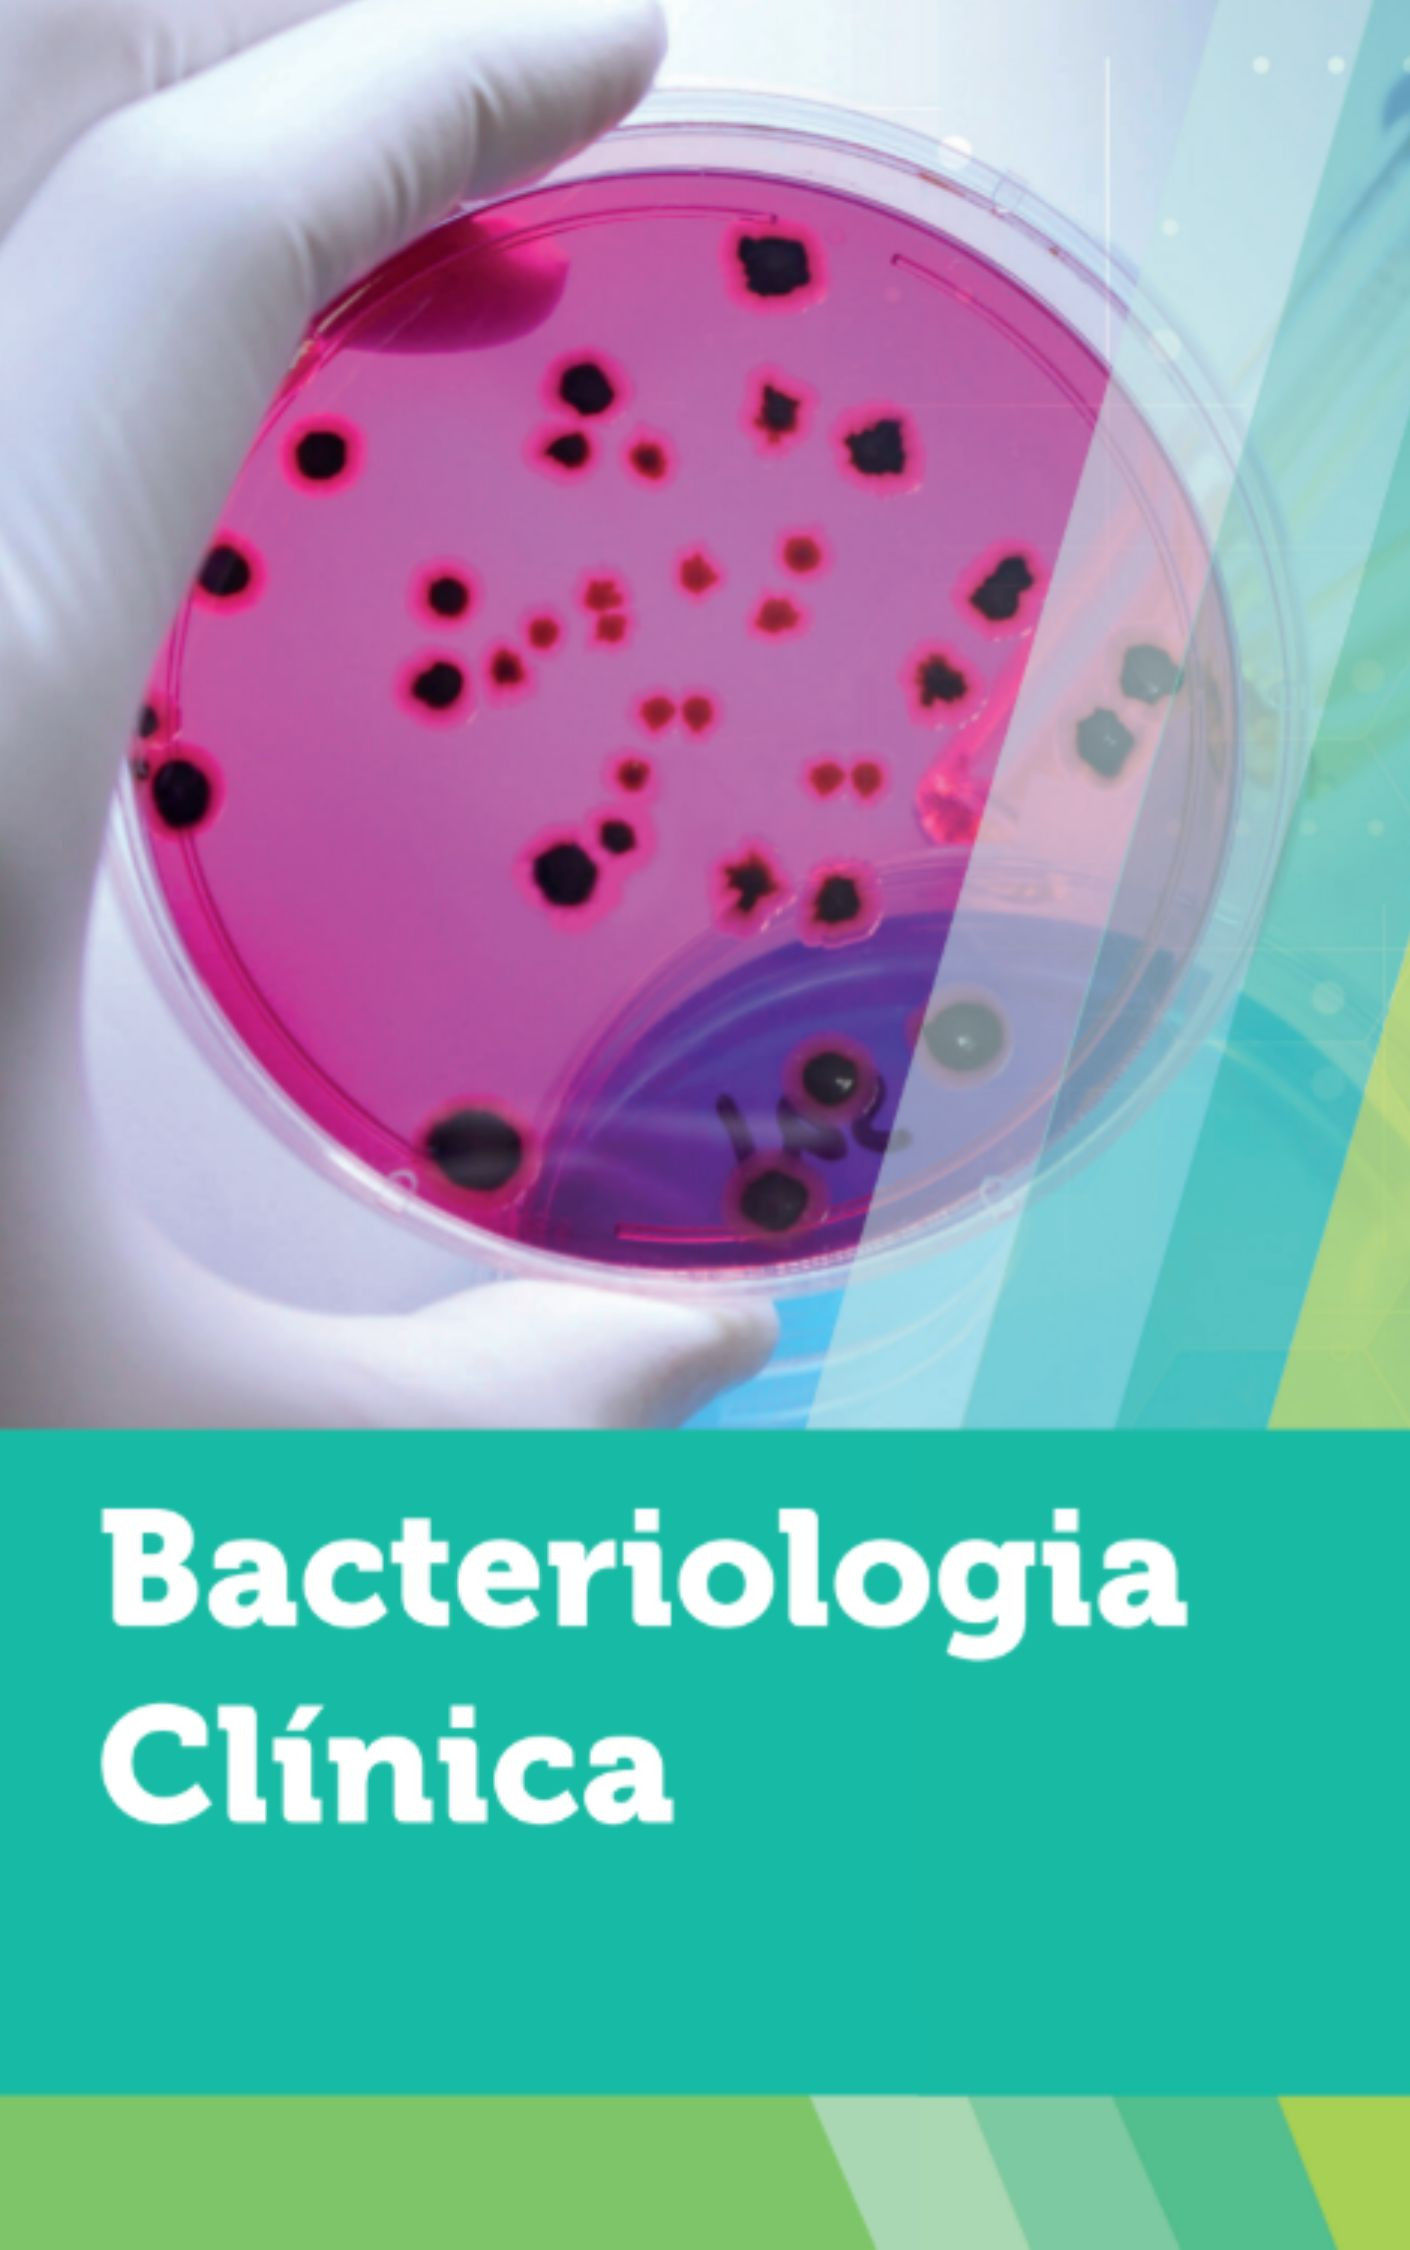

Biblioteca Virtual
Um espaço de crescimento e aprendizagem
A | B | C | D | E | F | G | H | I | J | K | L | M | N | O | P | Q | R | S | T | U | V | W | X | Y | Z | Todos
A |
|---|
| ES | A Arte de Enfermeiro: Escola de Enfermagem | |
|---|---|---|
Autor: Dr. Ângelo da Fonseca Leia o Livro Online | ||
| ES | A Face | |
|---|---|---|
Autores: Ralf J. Radlanski e Karl H. Wesker Leia o Livro Online | ||
| ES | A INTERPRETAÇÃO DA GASOMETRIA ARTERIAL | |
|---|---|---|
A interpretação da gasometria arterial envolve a análise do pH, PaCO2 (dióxido de carbono, relacionado aos pulmões) e bicarbonato (HCO3-), que é o componente renal, para identificar distúrbios ácido-básicos e avaliar a oxigenação. O processo de interpretação segue passos como determinar o status do pH (acidose ou alcalose), identificar a origem primária do distúrbio (respiratória ou metabólica) e verificar se há compensação do sistema pelo organismo. Leia o Livro Online | ||
| ES | A TIREÓIDE | |
|---|---|---|
A tireóide é a maior glândula endócrina do corpo humano, sendo responsável pela produção dos hor- Leia o Livro Online | ||
| ES | A educação permanente da equipe de enfermagem para o cuidado nos serviços de saúde mental | |
|---|---|---|
Estudo exploratório, cujo objetivo foi analisar a necessidade de educação permanente da equipe de enfermagem para o cuidar nos serviços de saúde mental. Foram estudados trinta e sete profissionais de enfermagem de saúde mental. Como resultados, verificou-se que a equipe de enfermagem de saúde mental demanda qualificação de amplo espectro. Conclui-se que a educação permanente da equipe de enfermagem de saúde mental exige, além de programas educacionais baseados em definição de competências específicas, processos educativos críticos que visem o desenvolvimento de conhecimentos Autora: Cláudia Mara de Melo Tavares Leia o Livro Online | ||
| ES | ABORTO E SAÚDE PÚBLICA | |
|---|---|---|
Autora: Debora Diniz e Marilena Corrêa Leia o Livro Online | ||
| ES | ABSCESSOS PULMONARES | |
|---|---|---|
Abscesso pulmonar é definido como uma infecção subaguda na qual a radiografia do tórax mostra uma cavidade dentro do parênquima pulmonar13. A fase inicial do desenvolvimento de um abscesso pulmonar é a pneumonia de aspiração, que a radiografia do tórax mostra como um infiltrado, representando uma pneumonia focai ou consolidação que evolui com necrose do parênquima. A formação do abscesso é uma complicação relativamente comum da pneumonia de aspiração, envolvendo anaeróbios. Isso se torna apa- rente na radiografia do tórax, quando uma área de necrose do parênquima comunica-se com um brônquio e drena, determinando o típico nível hidroaéreo1. É durante essa fase da infecção que aproximadamente 60% dos pacientes com abscessos anaeróbios têm o característico escarro fétido. Autores: Leandro Publio da Silva Leite, Raimundo Nonato de Sousa Andrade e Breno Machado Costa Leia o Livro Online | ||
| ES | ACESSOS VENOSOS EM EMERGÊNCIAS CLÍNICAS | |
|---|---|---|
Autores: URI ADRIAN PRYNC FLATO, ÍTALO SOUZA OLIVEIRA SANTOS e LUIZ EDUARDO FONTELES RITT Leia o Livro Online | ||
| ES | ADMINISTRAÇÃO DE MEDICAMENTOS POR VIA ENDOVENOSA | |
|---|---|---|
Autora: Profa. Ms. Priscila Cristina O. Zignani Pimentel Leia o Livro Online | ||
| ES | ANATOMIA E FISIOLOGIA | |
|---|---|---|
Leia o Livro Online | ||
| ES | ANATOMIA EM RADIOLOGIA | |
|---|---|---|
| ES | ANATOMIA RADIOGRÁFICA DENTO-MAXILOMANDIBULAR | |
|---|---|---|
A anatomia radiográfica dento-maxilo-mandibular estuda as estruturas de dentes, maxila e mandíbula como aparecem em radiografias odontológicas, sendo essencial para o diagnóstico, incluindo estruturas radiopacas (mais densas) como o osso, e radiolúcidas (menos densas) como cavidades. O estudo abrange o dente (esmalte, dentina, cemento), o osso alveolar, os seios maxilares, forames, canais e diversas outras estruturas ósseas e de tecidos moles, que podem ser visualizadas em exames como radiografias periapicais, panorâmicas e tomografias computadorizadas. Autora: Profa. Rosana da Silva Berticelli Leia o Livro Online | ||
| JB | ASSISTÊNCIA PEDIÁTRICA E NEONATAL EM UTI | |
|---|---|---|
Autor: Instituto Prominas Leia o livro Online | ||
| ES | ATUALIZAÇÃO EM MAMOGRAFIA | |
|---|---|---|
Um desses pontos é o reconhecimento dos aspectos anatômicos da mama. Esta é uma aula com importantes informações. Boa aula! Autora: Anna Maria Campos de Araújo Leia o Livro Online | ||
| ES | Administração na Saúde e na Enfermagem | |
|---|---|---|
Em primeiro lugar, é importante compreender que todas as ações dessa área partem da premissa de que saúde é resultado de inúmeros fatores sociais, tais como alimentação, renda, educação, meio ambiente, entre outros. Essa orientação da Organização Mundial de Saúde (OMS) é imple-mentada, em âmbito nacional, por políticas públicas que permeiam as esferas federal, estaduais e municipais de governo. Ao entender como fun-ciona a área de saúde, enfermeiros, técnicos e auxiliares podem conhecer melhor a dimensão de suas atribuições. Autores: Mercilda Bartmann, Ruth Túlio e Lucia Toyoshima | ||
| ES | Alterações Sistêmicas | |
|---|---|---|
Autora: Pamela Peres Leia o Livro Online | ||
| ES | Anatomia Aplicada á Odontologia | |
|---|---|---|
Autores: Lucilia Maria de Souza Teixeira, Peter Reher e Vanessa Goulart Sampaio Reher Leia o Livro Online | ||
| ES | Anatomia Arterial e Venosa Aplicada | |
|---|---|---|
“Aqueles que dissecaram ou inspecionaram, muito aprenderam, pelo menos a duvidar, enquanto os outros, que são ignorantes em ANATOMIA, e não se dão ao trabalho de observá-la, não apresentam absolutamente qualquer dúvida” Autor: Luiz Carlos Buarque de Gusmão Leia o Livro Online | ||
| ES | Anatomia Cabeça e Pescoço | |
|---|---|---|
Autora: Renata Georjutti Leia o Livro Online | ||
| ES | Anatomia Geral e Odontológica | |
|---|---|---|
Autor: Paulo Henrique Ferreira Caria Leia o Livro Online | ||
| ES | Anatomia da Face | |
|---|---|---|
Autor: Miguel Carlos Madeiro Leia o Livro Online | ||
| ES | Anatomia de Dentes Permanentes | |
|---|---|---|
 A anatomia do dente permanente envolve três partes principais: a coroa, visível na boca e coberta por esmalte; a raiz, que se fixa no osso alveolar e é revestida por cemento; e o colo, a zona de junção entre a coroa e a raiz. Cada dente possui ainda uma estrutura interna com a dentina (tecido sensível circundando o centro), a polpa (com vasos sanguíneos e nervos), e recebe o nome e função da sua localização, como incisivos, caninos e molares. A anatomia do dente permanente envolve três partes principais: a coroa, visível na boca e coberta por esmalte; a raiz, que se fixa no osso alveolar e é revestida por cemento; e o colo, a zona de junção entre a coroa e a raiz. Cada dente possui ainda uma estrutura interna com a dentina (tecido sensível circundando o centro), a polpa (com vasos sanguíneos e nervos), e recebe o nome e função da sua localização, como incisivos, caninos e molares.
Autor: Glauco Fioranelli Vieira
Leia o Livro Online | ||
| ES | Anatomia do Cérebro | |
|---|---|---|
O cérebro é o principal órgão do Encéfalo, pois quando falamos sobre o encéfalo lembramos somente do cérebro, porém não se esqueça que o tronco encefálico e o cerebelo também fazem parte do encéfalo. O cérebro é composto por duas partes: o Telencéfalo e o Diencéfalo, porém o cérebro propriamente dito com os hemisférios cerebrais direito e esquerdo como o conhecemos na anatomia pertence ao chamado Telencéfalo, e é a parte mais alta na hierarquia do sistema nervoso. Autor: Rogério Gozzi Leia o Livro Online | ||
| ES | Anatomia do Sistema Locomotor | |
|---|---|---|
Autores: Gustavo Graeff Kura e Marcos Roberto Spassim Leia o Livro Online | ||
| ES | Anatomia e Escultura Dental | |
|---|---|---|
Autor: Hilton Riquieri Leia o Livro Online | ||
| JB | Anatomia e Fisiologia Humana | |
|---|---|---|
Autora: Isabel Cristina Chagas Barbin Leia o livro Online | ||
| ES | Anatomia e fisiologia da mama Principais Problemas Mamários | |
|---|---|---|
Leia o Livro Online | ||
| ES | Anatomia normal da radiografia de tórax | |
|---|---|---|
A radiografia simples do tórax permite identificar um conjunto de estruturas e órgãos, incluindo os elementos da parede torácica (ossos e partes moles), cavidades pleurais, vias aéreas, hilos pulmonares, vasculatura pulmonar, mediastino, coração, aorta e pulmões direito e esquerdo. Este artigo visa abordar as principais representações das estruturas anatômicas contempladas pela radiografia de tórax através de um texto programado com exemplos e ilustrações baseadas em exames de nosso serviço.Inicialmente, é preciso atentar para a técnica, características do paciente e variantes anatômicas. É importante identificar as regiões das mamas, a bolha gástrica e a opacificação infradiafragmática direita pelo fígado. Da parte óssea, avaliamos principalmente as clavículas, região dos ombros, arcos costais, coluna torácica e o esterno. Os seios costofrênicos representam o principal marcador de doença da cavidade pleural. Devemos avaliar a via aérea central (principalmente traqueia e carina), os hilos pulmonares direito e esquerdo e a vasculatura pulmonar. É importante conhecer as estruturas que formam a silhueta cardiomediastinal normal, para assim poder identificar a presença de lesões mediastinais e sinais de doença cardiovascular. Já em relação à anatomia pulmonar, devemos lembrar que o pulmão direito é diferente do esquerdo e avaliação das imagens em PA e perfil é importante para localizar mais adequadamente as alterações radiográficas nos pulmões. Por último, mas não menos importante, devemos conhecer as principais variantes anatômicas identificadas no RX de tórax, com por exemplo a costela cervical, as calcificações costocondrais e o lobo acessório da veia ázigos. Autores: Danilo Tadao Wada, José Antonio Hiesinger Rodrigues e Marcel Koenigkam Santos Leia o Livro Online | ||
| ES | Anatomia, Histologia e Embriologia dosDentes e das Estruturas Orofaciais | |
|---|---|---|
Autores: Mary Bath-Balogh e Margaret J. Fehrenbach Leia o Livro Online | ||
| ES | Anatomiapara Colorir | |
|---|---|---|
Autor: John T. Hansen Leia o Livro Online | ||
| ES | Antibióticos em Endodontia | |
|---|---|---|
Autoras: Ezilmara Leonor Rolim de Sousa, Gabriela Garcia Torino e Gabriela Bülow Martins Leia o Livro Online | ||
| ES | Antimicrobianos de Cirurgia | |
|---|---|---|
Autores: ADÃO MACHADO e ELVINO BARROS Leia o Livro Online | ||
| ES | Assistência Nutricional na Obesidade e Doenças Cardiovasculares | |
|---|---|---|
Autores: Joyce Moraes Camarneiro, Maíra Branco Rodrigues e Celma Muniz Martins Leia o Livro Online | ||
| ES | Assistência Nutricional nas Patologias do Sistema Digestório e Órgãos Anexos | |
|---|---|---|
| ||
| ES | Assistência nutricional para gravemente enfermos | |
|---|---|---|
Autora: Iara Gumbrevicius Leia o Livro Online | ||
| JB | Atividades físicas e envelhecimento | |
|---|---|---|
Autor: Pedro Luiz Bulgarelli Leia o livro Online | ||
| ES | Atlas Anatomia Dental | |
|---|---|---|
Autor: Sam Leia o Livro Online | ||
| ES | Atlas Anatomia Oral | |
|---|---|---|
Autores: Matheus Luciell & Gabrieli Backes & Michel Calil Leia o Livro Online | ||
| ES | Atlas Cirúrgico na Implantodontia | |
|---|---|---|
Autor: Michael S. Block Leia o Livro Online | ||
| ES | Atlas Radiográfico Ossos e Articulações | |
|---|---|---|
O entendimento da anatomia radiológica humana é um conceito fundamental para muitas áreas da saúde. Saber identificar as estruturas radiológicas normais é o primeiro passo para reconhecer aquilo que está alterado, interpretar o exame e assim poder ajudar um paciente. Autores: Francisco Abaeté Neto, Leonardo M. Lustosa e João Erivan Façanha Barreto. Leia o Livro Online | ||
| ES | Atlas de Anatomia Humana | |
|---|---|---|
| ES | Atlas de Anatomia Radiográfica | |
|---|---|---|
Autores: Prof. Henrique Guilherme de Castro e Prof. José Otávio Guedes | ||
| ES | Atlas de Prótese sobre Implantes | |
|---|---|---|
Usando as últimas inovações tecnológicas e vários anos de experiência clinica, o novo implante foi desenvolvido para que as condições fisio-lógicas do osso alveolar recebesse a força e a transferisse de forma otimizada ao OSSO. Autor: Cone Morse Leia o Livro Online | ||
| AA | Atualidades em Farmácia I | |
|---|---|---|
Ao longo desta disciplina você conhecerá os conteúdos de abordagem específicas para a formação interdisciplinar do farmacêutico. Este livro será dividido em quatro unidades: na primeira unidade trabalharemos a atuação do farmacêutico no SUS, a seguir, estudos epidemiológicos e a atenção farmacêutica, na terceira unidade trabalharemos os principais pontos envolvidos na caracterização, desenvolvimento e melhoria da atividade de fármacos sintéticos e naturais, e, por fim, o estudo das influências das boas práticas de fabricação e manipulação na produção de medicamentos e alimentos com qualidade. Autores: Luciana Nogueira e Carolina de Oliveira Splendore Leia o Livro Online | ||
| AA | Atualidades em Farmácia II | |
|---|---|---|
Agora, continuaremos estudando sobre Atualidades em Farmácia. O conteúdo abordado nessa disciplina focará a formação interdisciplinar para sua atuação farmacêutica, com a qual você poderá adquirir conhecimentos que permitam que você desempenhe um excelente trabalho. Autor (a): Dreisson Aguilera de Oliveira Leia o livro Online | ||
| ES | Avaliação Nutricional | |
|---|---|---|
Autora: Iara Gumbrevicius Leia o Livro Online | ||
B |
|---|
| JB | Bacteriologia Clínica | |
|---|---|---|
Autora: Carolina de Oliveira Splendore Leia o livro Online | ||
| ES | Base da nutrição e dietética | |
|---|---|---|
Nesta disciplina, estudaremos o planejamento alimentar e a prescrição dietética. Autora: Karina Dantas Coelho Leia o Livro Online | ||
| ES | Bases da Radiografia (aula teórica) | |
|---|---|---|
A Radiologia tem como objetivo principal auxiliar o médico a estabelecer o diagnóstico, de forma precisa e rápida, utilizando imagens. Autor: Arnolfo de Carvalho Neto Leia o Livro Online | ||
| ES | Bases da dietoterapia | |
|---|---|---|
Autora: Paula Pens Alves Okazaki Leia o Livro Online | ||
| ES | Biologia Celular e Molecular | |
|---|---|---|
Autor: Lucas Detogni Simi Leia o Livro Online | ||
| ES | Biologia molecular e evolução | |
|---|---|---|
Autora: Larissa Barbosa de Paula Leia o Livro Online | ||
| ES | Bioquímica Oral | |
|---|---|---|
Autores: Jaime A. Cury, Livia Maria Andaló Tenuta e Cínthia P. M. Tabchoury Leia o Livro Online | ||
| ES | Biossegurança nas Ações de Enfermagem | |
|---|---|---|
Leia o Livro Online | ||
| ES | Bioética e biossegurança | |
|---|---|---|
Neste livro você terá acesso a todas as informações relacionadas à Bioética e Autor: Paulo Heraldo Costa do Valle Leia o Livro Online | ||
| ES | Bioética e legislação em enfermagem | |
|---|---|---|
Autora: Milena de Oliveira Sampaio Leia o Livro Online | ||
C |
|---|
| ES | CONCEITOS BÁSICOS DE QUÍMICA | |
|---|---|---|
Autores: Gesilane de Oliveira Maciel José e Geziel Rodrigues de Andrade. Leia o Livro Online | ||
| ES | Cariologia | |
|---|---|---|
Autor: Frederico Barbosa de Sousa Leia o Livro Online | ||
| ES | Cariologia: Conceitos Básicos, Diagnóstico e Tratamento Não Restaurador | |
|---|---|---|
Autores: Marisa Maltz, Livia Maria Andaló Tenuta, Sonia Groisman e Jaime A. Cury Leia o Livro Online | ||
| ES | Cariologia: Conceitos Básicos, Diaginóstico e Tratamento Não Restaurador | |
|---|---|---|
Autores: Marisa Maltz, Livia Maria Andaló Tenuta, Sonia Groisman e Jaime A. Cury Leia o Livro Online | ||
| ES | Casos Clínicos de Ortodontia na Odontopediatria | |
|---|---|---|
Autores: Declan Millett e Richard Welbury Leia o Livro Online | ||
| ES | Cirurgia Estética Periodontal | |
|---|---|---|
Autores: Cesário Antonio Duarte e Marcos Vinícius Moreira de Castro Leia o Livro Online | ||
| ES | Cirurgia Oral e Maxilofacial | |
|---|---|---|
Autores: JAMES R. HUPP, EDWARD ELLIS III e MYRON R. TUCKER Leia o Livro Online | ||
| JB | Ciências Morfofuncionais do Aparelho Locomotor - Membros Inferiores e Coluna Vertebral | |
|---|---|---|
Autor: João Paulo Manfré dos Santos Leia o livro Online | ||
| JB | Ciências Morfofuncionais do Aparelho Locomotor - Membros Superiores, Cabeça e Tronco | |
|---|---|---|
Autora: Mailme de Souza Oliveira Leia o livro Online | ||
| JB | Ciências Morfofuncionais dos Sistemas Imune e Hematológico | |
|---|---|---|
Autora: Isabel Cristina Chagas Barbin Leia o livro Online | ||
| JB | Ciências morfofuncionais dos sistemas digestório, endócrino e renal | |
|---|---|---|
Autora: Ana Cláudia Bensuaski Paula Zurron Leia o livro Online | ||
| JB | Ciências morfofuncionais dos sistemas nervoso e cardiorrespiratório | |
|---|---|---|
Autor: Paulo Heraldo Costa do Valle Leia o livro Online | ||
| JB | Ciências morfofuncionais dos sistemas tegumentar, reprodutor e locomotor | |
|---|---|---|
O estudo desta unidade encontra-se inserido na grande área do conhecimento científico das Ciências Morfofuncionais, que engloba as áreas do conhecimento de Anatomia Macroscópica, Fisiologia e Histologia e Embriologia. Autora: Isabella Alice Gotti Leia o livro Online | ||
| ES | Clínica Integrada em Odontologia | |
|---|---|---|
Autor: Rodney Garcia Rocha Leia o Livro Online | ||
| ES | Condutas Atuais em QUEIMADURAS | |
|---|---|---|
Estima-se que no Brasil ocorram em torno de 1.000.000 de acidentes/ano, sendo que 100.000 pacientes procurarão atendimento hospitalar e, destes, cerca de 2.500 pacientes irão falecer direta ou indiretamente de suas lesões. Autores: DINO ROBERTO GOMES, MARIA CRISTINA SERRA e LUIZ MACIEIRA GUIMARÃES JR. Leia o Livro Online | ||
| JB | Cálculo de Dosagem e Preparação de Medicamentos | |
|---|---|---|
Autor: Mary Jo Boyer Leia o livro Online | ||
| ES | Cárie Dentária | |
|---|---|---|
A bistopatologia da carie dentária fornece parâmetros passíveis de uti hzação em avaliações clínico-radiográficas de procedimentos preventivos e operatórios, quando for necessaria a mensuração das modificações celu-lares e teciduats que caractenzam o processo Autor: Alberto Consolaro Leia o Livro Online | ||
| ES | Cárie DentáriaA Doença e seu Tratamento Clínico | |
|---|---|---|
Autores: Ole Fejerskov e Edwina Kidd Leia o Livro Online | ||
D |
|---|
| ES | DISCIPLINA: ANATOMIA E FISIOLOGIA HUMANA | |
|---|---|---|
Fisiologia: do grego, physic = ‘natureza’ + logos = ‘estudo’, estudo da natureza. É a parte da ciência que estuda o funcionamento dos seres vivos. A fisiologia tenta explicar os fatores físicos e químicos responsáveis pela origem, desenvolvimento e progressão da vida. Cada tipo de vida, desde o mais simples vírus até a maior árvore Autor: Ms. RICARDO RODRIGUES Leia o Livro Online | ||
| JB | Diagnóstico cinético- funcional e imaginologia - membros inferiores e coluna vertebral | |
|---|---|---|
Autor: Sérgio de Souza Pinto Leia o livro Online | ||
| JB | Diagnósticos de Enfermagem da NANDA | |
|---|---|---|
Autora: NANDA Internacional Leia o livro Online | ||
| ES | Diferenças entre Sistema Nervoso Somático e Sistema Nervoso Autônomo | |
|---|---|---|
A diferença principal é que o Sistema Nervoso Somático é voluntário, controlando os movimentos dos músculos esqueléticos e os sentidos, enquanto o Sistema Nervoso Autônomo é involuntário, regulando funções internas do corpo como a frequência cardíaca, a digestão e a respiração. Autor: Rogério Gozzi Leia o Livro Online | ||
| ES | Disjunção Maxilar | |
|---|---|---|
Autor: Mario Cappellette JR. Leia o Livro Online | ||
| ES | Distúrbios Respiratórios na Infância | |
|---|---|---|
Autoras: Maria Teresa Martins e Maria Christina Thomé Leia o Livro Online | ||
| JB | Doenças Infecciosas e Doenças Infecciosas e Doenças Infecciosas e Parasitárias arasitárias arasitárias Aspectos Clínicos, Vigilância Epidemiológica e Aspectos Clínicos, Vigilância Epidemiológica e Medidas de Controle | |
|---|---|---|
Autor: FUNASA / Ministério da Saúde Leia o livro Online | ||
E |
|---|
| ES | ECG Manual Prático de Eletrocardiograma | |
|---|---|---|
Autor: Helder José Lima Rei Leia o Livro Online | ||
| ES | ECG: PRIMEIROS PASSOS | |
|---|---|---|
Autores: Nickson Breno Maniçoba, Carlos Ademar Dias Arruda Filho e Elcias Camurça Júnior Leia o Livro Online | ||
| JB | EMERGÊNCIAS PSIQUIÁTRICAS | |
|---|---|---|
Autores: João Quevedo, André F. Carvalho Leia o livro Online | ||
| ES | ENFERMAGEM CLÍNICA CIRÚRGICA | |
|---|---|---|
Leia o Livro Online | ||
| ES | ENFERMAGEM EM CLÍNICA MÉDICA | |
|---|---|---|
Leia o Livro Online | ||
| ES | ENFERMAGEM EM PEDIATRIA | |
|---|---|---|
Leia o Livro Online | ||
| ES | Efeitos fisiológicos do Sistema Nervoso Autônomo Simpático e Parassimpático | |
|---|---|---|
O sistema nervoso autônomo tem duas ramificações principais: o simpático, que prepara o corpo para a ação em situações de "luta ou fuga", aumentando a frequência cardíaca e o fluxo sanguíneo para os músculos, e o parassimpático, que atua em momentos de "descanso e digestão", promovendo o relaxamento, a digestão e o retorno do corpo aos níveis normais de atividade. Autor: Rogério Gozzi Leia o Livro Online | ||
| ES | Endodontia Laboratorial e Clínica | |
|---|---|---|
Autor: Carlos Estrela Leia o Livro Online | ||
| ES | Enfermagem Materno Infantil | |
|---|---|---|
Leia o Livro Online | ||
| JB | Enfermagem em Centro Cirúrgico | |
|---|---|---|
Autora: Milena de Oliveira Sampaio Leia o livro Online | ||
| ES | Enfermagem na Saúde da Criança e do Adolescente | |
|---|---|---|
Autor: Emanuel Nunes Leia o Livro Online | ||
| JB | Enfermagem na Saúde da Mulher | |
|---|---|---|
Autora: Ana Carolina de Castro Curado Leia o livro Online | ||
| JB | Enfermagem na saúde do adulto | |
|---|---|---|
Autora: Marcia Cristina Aparecida Thomaz Leia o livro Online | ||
| JB | Enfermagem na saúde do idoso | |
|---|---|---|
Autora: Anna Carla Moleta Leia o livro Online | ||
| ES | Epidemiologia Nutricional | |
|---|---|---|
Autora: Bruna Cruz Magalhães Leia o Livro Online | ||
| ES | Ergonomia e Biossegurança em Odontologia | |
|---|---|---|
Autores: Wilson Galvão Naressi, Eliel Soares Orenha e Suely Carvalho Mutti Naressi Leia o Livro Online | ||
| ES | Estratégia da saúde da família | |
|---|---|---|
Prezado aluno! Para que possamos dar continuidade aos conceitos já vistos relacionados à saúde coletiva, renovamos o convite para que, a partir de agora, possamos adentrar em uma das estratégias que vêm sendo implementadas com mais ênfase nos últimos anos pelo Ministério da Saúde brasileiro como forma de prover e promover o cuidado a partir da atenção primária em saúde, ou seja, a Estratégia da saúde da família. Estaremos abordando nesta disciplina o aprofundamento de conhecimentos relacionados às políticas de saúde no Brasil e no mundo, as principais justificativas para a aposta nesta estratégia, os grupos prioritários para a garantia do cuidado em saúde, a organização estrutural e do processo de trabalho neste nível de atenção. Autora: Simone Nunes Pinto Leia o Livro Online | ||
F |
|---|
| ES | FACIAL TOPOGRAPHY | |
|---|---|---|
Autores: Joel E. Pessa e Rod J. Rohrich Leia o Livro Online | ||
| ES | FARMACOLOGIA | |
|---|---|---|
Se uma substância tem propriedade medicinal, ela é considerada farmacêutica. Leia o Livro Online | ||

 A decisão governamental de fundir numa única instituição os duas escolas públicas de ensino superior da enfermagem de Coimbra está na origem deste livro. Momento de passagem carregado de forte simbolismo, a ocasião foi aproveitada pela última direcção da Escola Superior de Enfermagem Dr. Angelo da Fonseca, represen-tada pelo Professor Doutor António de Jesus Couto e pela Dra. Ana Paula Camarneiro, para, em nome da preservação da memória futura, aprofundar o conhe-cimento histórico do estabelecimento de ensino. Se bem se pensou, assim se fez e, de imediato, se avançou para a organização do arquivo da instituição, tarefa que foi levada a cabo, com dedicação, entusiasmo e competência, pelo arquivista Dr. Rui Lopes, com o apoio do Arquivo da Universidade de Coimbra e sob orientação do Dr. Júlio Ramos.
A decisão governamental de fundir numa única instituição os duas escolas públicas de ensino superior da enfermagem de Coimbra está na origem deste livro. Momento de passagem carregado de forte simbolismo, a ocasião foi aproveitada pela última direcção da Escola Superior de Enfermagem Dr. Angelo da Fonseca, represen-tada pelo Professor Doutor António de Jesus Couto e pela Dra. Ana Paula Camarneiro, para, em nome da preservação da memória futura, aprofundar o conhe-cimento histórico do estabelecimento de ensino. Se bem se pensou, assim se fez e, de imediato, se avançou para a organização do arquivo da instituição, tarefa que foi levada a cabo, com dedicação, entusiasmo e competência, pelo arquivista Dr. Rui Lopes, com o apoio do Arquivo da Universidade de Coimbra e sob orientação do Dr. Júlio Ramos. Todas as disciplinas médicas que tratam da face humana devem contar com o conhecimento exato de sua anatomia topográfica altamente complexa. Nesta obra, pensamos em cirurgiões plásticos faciais, dermatologistas, otorrinolaringologistas, cirurgiões bucais, ortodontistas e cirurgiões-dentistas. A esta lista devem ser adicionados fisioterapeutas que trabalham no campo das disfunções temporomandibulares e os fonoaudiólogos; para esses profissionais também é obrigatório o conhecimento minucioso da região orofacial.
Todas as disciplinas médicas que tratam da face humana devem contar com o conhecimento exato de sua anatomia topográfica altamente complexa. Nesta obra, pensamos em cirurgiões plásticos faciais, dermatologistas, otorrinolaringologistas, cirurgiões bucais, ortodontistas e cirurgiões-dentistas. A esta lista devem ser adicionados fisioterapeutas que trabalham no campo das disfunções temporomandibulares e os fonoaudiólogos; para esses profissionais também é obrigatório o conhecimento minucioso da região orofacial. O projeto que deu origem a este relatório sistematizou 20 anos de publicações sobre o tema do aborto no Brasil. O objetivo foi, por um lado, fortalecer a agenda nacional de pesquisas sobre aborto, organizando o conhecimento disperso, e, por outro, aproximar o debate político da produção acadêmica brasileira. O resultado foi a recuperação de 2.135 fontes em Língua Portuguesa, publicadas por autores, periódicos e editoras nacionais ou estrangeiros.
O projeto que deu origem a este relatório sistematizou 20 anos de publicações sobre o tema do aborto no Brasil. O objetivo foi, por um lado, fortalecer a agenda nacional de pesquisas sobre aborto, organizando o conhecimento disperso, e, por outro, aproximar o debate político da produção acadêmica brasileira. O resultado foi a recuperação de 2.135 fontes em Língua Portuguesa, publicadas por autores, periódicos e editoras nacionais ou estrangeiros. Novas evidências científicas1,2,3 modificaram a utilização de acessos para a administração de medicamentos. Atualmente, utilizamos as vias de administração intravenosa (IV), intra-óssea (IO) e endotraqueal (ET).
Novas evidências científicas1,2,3 modificaram a utilização de acessos para a administração de medicamentos. Atualmente, utilizamos as vias de administração intravenosa (IV), intra-óssea (IO) e endotraqueal (ET). Via intravenosa é aquela que permite o acesso de um medicamento ou outra solução ao organismo através de injeção direta em uma veia. Para tanto, é necessário fazer uma punção venosa e utilizar uma agulha longa, capaz de penetrar os tecidos subcutâneo e muscular para alcançar o vaso sanguíneo.
Via intravenosa é aquela que permite o acesso de um medicamento ou outra solução ao organismo através de injeção direta em uma veia. Para tanto, é necessário fazer uma punção venosa e utilizar uma agulha longa, capaz de penetrar os tecidos subcutâneo e muscular para alcançar o vaso sanguíneo. Anatomia é a ciência que estuda a estrutura e a organização dos seres vivos, tanto interna quanto externamente. Enquanto que a fisiologia estuda o funcionamento do organismo.
Anatomia é a ciência que estuda a estrutura e a organização dos seres vivos, tanto interna quanto externamente. Enquanto que a fisiologia estuda o funcionamento do organismo. Segundo a Portaria GM/GS no 3432/98, as Unidades de Terapia Intensiva (UTIs) são unidades hospitalares destinadas ao atendimento de pacientes graves ou de risco que dispõem de assistência e de enfermagem ininterruptas, com equipamentos específicos próprios, recursos humanos especializados, e que têm acesso a outras tecnologias destinadas ao diagnóstico e terapêutica.
Segundo a Portaria GM/GS no 3432/98, as Unidades de Terapia Intensiva (UTIs) são unidades hospitalares destinadas ao atendimento de pacientes graves ou de risco que dispõem de assistência e de enfermagem ininterruptas, com equipamentos específicos próprios, recursos humanos especializados, e que têm acesso a outras tecnologias destinadas ao diagnóstico e terapêutica. Esse é o material didático do curso de Atualização em Mamografia para Técnicos em Radiologia.
Esse é o material didático do curso de Atualização em Mamografia para Técnicos em Radiologia. Por que os profissionais de enfermagem precisam saber como se orga-nizam os serviços de saúde e de enfermagem?
Por que os profissionais de enfermagem precisam saber como se orga-nizam os serviços de saúde e de enfermagem? Os autores deste livro e a EDITORA GUANABARA KOOGAN LTDA. empenharam seus melhores esforços para assegurar que as informações e os procedimentos apresentados no texto estejam em acordo com os padrões aceitos à época da publicação, e todos os dados foram atualizados pelo autor até a data da entrega dos originais à editora. Entretanto, tendo em conta a evolução das ciências da saúde, as mudanças regulamentares governamentais e o constante fluso de novas informações sobre terapèutica medicamentosa e reações adversas a fármacos, recomendamos enfaticamente que os leitores consultem sempre outras fontes fidedignas, de modo a se certificarem de que as informações contidas neste livro estão corretas e de que não houve alterações nas dosagens recomendadas ou na legalação regulamentadora.
Os autores deste livro e a EDITORA GUANABARA KOOGAN LTDA. empenharam seus melhores esforços para assegurar que as informações e os procedimentos apresentados no texto estejam em acordo com os padrões aceitos à época da publicação, e todos os dados foram atualizados pelo autor até a data da entrega dos originais à editora. Entretanto, tendo em conta a evolução das ciências da saúde, as mudanças regulamentares governamentais e o constante fluso de novas informações sobre terapèutica medicamentosa e reações adversas a fármacos, recomendamos enfaticamente que os leitores consultem sempre outras fontes fidedignas, de modo a se certificarem de que as informações contidas neste livro estão corretas e de que não houve alterações nas dosagens recomendadas ou na legalação regulamentadora. Essa apostila de Anatomia da cabeça e pescoço foi criada com o intuito de ajudar os alunos de forma didática e criativa, de
Essa apostila de Anatomia da cabeça e pescoço foi criada com o intuito de ajudar os alunos de forma didática e criativa, de A intenção era continuar a oferecer uma anatomia específica da face, porém acrescida de noções de anatomia humana geral, como se fossem dois compêndios em um só. A justificativa era que a união desses assuntos correspondia ao conteúdo total da discipli-na de Anatomia, do curso de Odontologia. Apesar de mais con-pleto, continuaria a ser um livro apenas, o que traria vantagem econômica na sua aquisição.
A intenção era continuar a oferecer uma anatomia específica da face, porém acrescida de noções de anatomia humana geral, como se fossem dois compêndios em um só. A justificativa era que a união desses assuntos correspondia ao conteúdo total da discipli-na de Anatomia, do curso de Odontologia. Apesar de mais con-pleto, continuaria a ser um livro apenas, o que traria vantagem econômica na sua aquisição. Com as novas exigências curriculares nos diferentes cursos das áreas da Saúde, os períodos de aula destinados ao ensino da Anatomia Humana vêm diminuindo progressivamente, o que exige a publicação de livros-texto cada vez mais concisos, ou direcionados a um único tópico, adaptados a uma área específica de atuação profissional. Atentos aos recursos disponíveis da informática passíveis de serem aplicados nas mais diferentes áreas do conhecimento, os anatomistas da atualidade, ao se utilizarem dessa importante ferramenta de trabalho, visam não somente a suprir o tempo cada vez mais exíguo despendido em laboratórios, como também a auxiliar os docentes e discentes nas práticas pedagógicas de apoio à construção do conhecimento.
Com as novas exigências curriculares nos diferentes cursos das áreas da Saúde, os períodos de aula destinados ao ensino da Anatomia Humana vêm diminuindo progressivamente, o que exige a publicação de livros-texto cada vez mais concisos, ou direcionados a um único tópico, adaptados a uma área específica de atuação profissional. Atentos aos recursos disponíveis da informática passíveis de serem aplicados nas mais diferentes áreas do conhecimento, os anatomistas da atualidade, ao se utilizarem dessa importante ferramenta de trabalho, visam não somente a suprir o tempo cada vez mais exíguo despendido em laboratórios, como também a auxiliar os docentes e discentes nas práticas pedagógicas de apoio à construção do conhecimento. Neste livro intitulado "Anatomia e Escultura Dental", a responsabilidade aumenta ainda mais o prazer, e a honra de fazê-lo torna-se incomensurá-vel. Vou explicar: esta obra com mais de 300 páginas é um presente para a Odontologia porque foi elaborada por um dos profissionais que melhor executa os enceramentos com bases na morfologia dental.
Neste livro intitulado "Anatomia e Escultura Dental", a responsabilidade aumenta ainda mais o prazer, e a honra de fazê-lo torna-se incomensurá-vel. Vou explicar: esta obra com mais de 300 páginas é um presente para a Odontologia porque foi elaborada por um dos profissionais que melhor executa os enceramentos com bases na morfologia dental. Prezado aluno! Bem-vindo aos estudos da disciplina de Anatomia e Fisiologia Humana! Esta disciplina é base da formação do profissional que trabalha com a biologia do ser humano. As informações aprendidas nessa área futuramente serão associadas às áreas voltadas à funcionalidade do organismo humano e às patologias que o acometem, proporcionando, assim, a consolidação do aprendizado do ser humano biologicamente. Ela aborda a constituição macroscópica dos sistemas orgânicos do corpo humano, assim como sua funcionalidade.
Prezado aluno! Bem-vindo aos estudos da disciplina de Anatomia e Fisiologia Humana! Esta disciplina é base da formação do profissional que trabalha com a biologia do ser humano. As informações aprendidas nessa área futuramente serão associadas às áreas voltadas à funcionalidade do organismo humano e às patologias que o acometem, proporcionando, assim, a consolidação do aprendizado do ser humano biologicamente. Ela aborda a constituição macroscópica dos sistemas orgânicos do corpo humano, assim como sua funcionalidade. A mama é um órgão glandular na região anterior do tórax, responsável pela produção de leite na mulher, sendo rudimentar no homem. A fisiologia envolve o desenvolvimento glandular e a lactação, regulados por hormônios como estrogénio e prolactina. Os principais problemas incluem o câncer de mama, cistos, fibroadenomas (nódulos benignos), mastalgia (dor mamária) e ginecomastia (aumento da mama masculina). Qualquer alteração como nódulos, dor persistente, secreção ou alterações visuais deve ser avaliada por um médico para diagnóstico precoce.
A mama é um órgão glandular na região anterior do tórax, responsável pela produção de leite na mulher, sendo rudimentar no homem. A fisiologia envolve o desenvolvimento glandular e a lactação, regulados por hormônios como estrogénio e prolactina. Os principais problemas incluem o câncer de mama, cistos, fibroadenomas (nódulos benignos), mastalgia (dor mamária) e ginecomastia (aumento da mama masculina). Qualquer alteração como nódulos, dor persistente, secreção ou alterações visuais deve ser avaliada por um médico para diagnóstico precoce. Esta obra oferece um extenso conhecimento na área de biologia oral aos profissionais de odontologia, assim como aos alunos de programas de pós-graduação que precisam fazer exames de competência ou atualizar os seus conhecimentos nesta área. Este livro é dividido em quatro unidades: Revisão das Estruturas Dentais, Embriologia Dental, Histologia Dental
Esta obra oferece um extenso conhecimento na área de biologia oral aos profissionais de odontologia, assim como aos alunos de programas de pós-graduação que precisam fazer exames de competência ou atualizar os seus conhecimentos nesta área. Este livro é dividido em quatro unidades: Revisão das Estruturas Dentais, Embriologia Dental, Histologia Dental A anatomia humana é um tema fascinante e complexo, um dos assuntos realmente interessantes para todos nós. Aprender
A anatomia humana é um tema fascinante e complexo, um dos assuntos realmente interessantes para todos nós. Aprender O livro Antibióticos em Endodontia: Por Que, Como e Quando Usálos, de autoria da Profa. Dra. Ezilmara
O livro Antibióticos em Endodontia: Por Que, Como e Quando Usálos, de autoria da Profa. Dra. Ezilmara O uso de antimicrobianos faz parte da prescrição no dia-a-dia do médico nas diversas especialidades cirúrgicas. Nossa principal idéia foi desenvolver um livro de pequeno porte, fácil de carregar, mas acima de tudo fácil de consultar e que realmente respondesse as perguntas que a toda hora surgem. Qual é a dose? Quais são as apresentações? Como ajustar as doses nos pacientes com redução da função renal ou hepática? Tem interações medicamentosas? Efeitos adversos? Essas e outras questões foram abordadas, com rigorosa pesquisa científica e muitas horas de ajuste do texto para que as informações ficassem claras e concisas. Todos os antimicrobianos disponiveis no mercado nacional são apresentados neste livro, de forma simples e prática, preenchendo as necessidades do médico cirurgião.
O uso de antimicrobianos faz parte da prescrição no dia-a-dia do médico nas diversas especialidades cirúrgicas. Nossa principal idéia foi desenvolver um livro de pequeno porte, fácil de carregar, mas acima de tudo fácil de consultar e que realmente respondesse as perguntas que a toda hora surgem. Qual é a dose? Quais são as apresentações? Como ajustar as doses nos pacientes com redução da função renal ou hepática? Tem interações medicamentosas? Efeitos adversos? Essas e outras questões foram abordadas, com rigorosa pesquisa científica e muitas horas de ajuste do texto para que as informações ficassem claras e concisas. Todos os antimicrobianos disponiveis no mercado nacional são apresentados neste livro, de forma simples e prática, preenchendo as necessidades do médico cirurgião. Caro aluno, o objetivo desta disciplina é conhecer os aspectos fisiológicos, metabólicos e o tratamento para obesidade, das doenças cardiovasculares e da síndrome metabólica. É um tema relevante devido à prevalência dessas doenças no Brasil. Para entender com mais complexidade as características das doenças, é necessário conhecer o estado nutricional dos indivíduos com obesidade, doenças cardiovasculares e com síndrome metabólica para planejar, prescrever, analisar, supervisionar e avaliar suas dietas utilizando o raciocínio clínico específico na abordagem dietoterápica.
Caro aluno, o objetivo desta disciplina é conhecer os aspectos fisiológicos, metabólicos e o tratamento para obesidade, das doenças cardiovasculares e da síndrome metabólica. É um tema relevante devido à prevalência dessas doenças no Brasil. Para entender com mais complexidade as características das doenças, é necessário conhecer o estado nutricional dos indivíduos com obesidade, doenças cardiovasculares e com síndrome metabólica para planejar, prescrever, analisar, supervisionar e avaliar suas dietas utilizando o raciocínio clínico específico na abordagem dietoterápica. Prezado aluno, a disciplina Assistência Nutricional nas Patologias do Sistema Digestório e Órgãos Anexos é de extrema importância para o profissional nutricionista, uma vez que envolve todos os processos biológicos relacionados à ingestão alimentar, mastigação, deglutição, digestão, absorção e excreção. O objetivo
Prezado aluno, a disciplina Assistência Nutricional nas Patologias do Sistema Digestório e Órgãos Anexos é de extrema importância para o profissional nutricionista, uma vez que envolve todos os processos biológicos relacionados à ingestão alimentar, mastigação, deglutição, digestão, absorção e excreção. O objetivo Prezado aluno, bem-vindo à disciplina Assistência Nutricional
Prezado aluno, bem-vindo à disciplina Assistência Nutricional O tema “Atividades físicas e envelhecimento” ganhou e continua ganhando muito espaço na Educação Física, principalmente devido ao aumento da expectativa de vida da população em geral, refletindo assim no aumento da população idosa no país, população essa que requer atenção especial principalmente quando se trata de exercício físico e saúde.
O tema “Atividades físicas e envelhecimento” ganhou e continua ganhando muito espaço na Educação Física, principalmente devido ao aumento da expectativa de vida da população em geral, refletindo assim no aumento da população idosa no país, população essa que requer atenção especial principalmente quando se trata de exercício físico e saúde. A Anatomia Dental estuda a estrutura e formação dos dentes, que são compostos por coroa (parte visível), colo (junção entre coroa e raiz) e raiz (fixada no osso alveolar).
A Anatomia Dental estuda a estrutura e formação dos dentes, que são compostos por coroa (parte visível), colo (junção entre coroa e raiz) e raiz (fixada no osso alveolar).  A Anatomia Oral estuda as estruturas da cavidade bucal, que incluem lábios, bochechas, palato (duro e mole), língua, dentes e gengivas, além de glândulas salivares, músculos e nervos.
A Anatomia Oral estuda as estruturas da cavidade bucal, que incluem lábios, bochechas, palato (duro e mole), língua, dentes e gengivas, além de glândulas salivares, músculos e nervos.  Compreender como realizar uma técnica cirúrgica geralmente necessita de uma leitura como base, observando o procedimento que está sendo realizado, executando o procedimento sob supervisão, avaliando os resultados e, então, ensinando o método a outros. O princípio “veja, faça, ensine” é utilizado repetitivamente em todos os programas de treinamento. Em um livro, o prossional pode ver o momento exato foto a foto, mas ver o momento real do descolamento periosteal, o método de afastamento, e o ângulo de corte dos instrumentos é uma parte muito importante da educação, quando o prossional está aprendendo a utilizar o novo método.
Compreender como realizar uma técnica cirúrgica geralmente necessita de uma leitura como base, observando o procedimento que está sendo realizado, executando o procedimento sob supervisão, avaliando os resultados e, então, ensinando o método a outros. O princípio “veja, faça, ensine” é utilizado repetitivamente em todos os programas de treinamento. Em um livro, o prossional pode ver o momento exato foto a foto, mas ver o momento real do descolamento periosteal, o método de afastamento, e o ângulo de corte dos instrumentos é uma parte muito importante da educação, quando o prossional está aprendendo a utilizar o novo método. O Atlas Radiográfico Ilustrado: Ossos e Articulações, é um e-book organizado pelos autores Leonardo Lustosa, Francisco Abaeté e Erivan Façanha destinado para alunos da graduação no estudo da anatomia radiológica humana.
O Atlas Radiográfico Ilustrado: Ossos e Articulações, é um e-book organizado pelos autores Leonardo Lustosa, Francisco Abaeté e Erivan Façanha destinado para alunos da graduação no estudo da anatomia radiológica humana.
 Em 1895, o físico alemão, Wilhelm Cronrad Roentgen, estudava os fenômenos da luminescência dos raios catódicos, quando detectou, pela primeira vez, um tipo de radiação desconhecida, a qual chamou raios X. A experiência de Roentgen forneceu a base técnica para obtenção da radiografia. Essa técnica consiste na emissão de um feixe de raios catódicos vindos de uma ampola de raios X que atravessa os tecidos de forma heterogênea de acordo com a densidade de cada um e atinge uma película ou filme, gerando imagens. Tecidos mais densos, como os ossos, retêm melhor os raios e projetam imagens brancas no filme. Enquanto isso, tecidos moles, como pele e tecido adiposo, e espaços preenchidos por ar ou líquido, são atravessados com maior facilidade, gerando imagens mais escuras. Assim, a imagem projetada na película terá áreas que vão do branco, passam pelo cinza e chegam ao preto.
Em 1895, o físico alemão, Wilhelm Cronrad Roentgen, estudava os fenômenos da luminescência dos raios catódicos, quando detectou, pela primeira vez, um tipo de radiação desconhecida, a qual chamou raios X. A experiência de Roentgen forneceu a base técnica para obtenção da radiografia. Essa técnica consiste na emissão de um feixe de raios catódicos vindos de uma ampola de raios X que atravessa os tecidos de forma heterogênea de acordo com a densidade de cada um e atinge uma película ou filme, gerando imagens. Tecidos mais densos, como os ossos, retêm melhor os raios e projetam imagens brancas no filme. Enquanto isso, tecidos moles, como pele e tecido adiposo, e espaços preenchidos por ar ou líquido, são atravessados com maior facilidade, gerando imagens mais escuras. Assim, a imagem projetada na película terá áreas que vão do branco, passam pelo cinza e chegam ao preto. Um sistema inovador, o sistema de implantes Ankylos foi desenvolvido pelo Prof. Dr. G. H. Nentwig e Dr. W Moser em 1985 com a proposta de reproduzir as caracteristicas protéticas de um dente natural.
Um sistema inovador, o sistema de implantes Ankylos foi desenvolvido pelo Prof. Dr. G. H. Nentwig e Dr. W Moser em 1985 com a proposta de reproduzir as caracteristicas protéticas de um dente natural. Prezado aluno, seja bem-vindo à disciplina de Atualidades em Farmácia I. Nela, você terá a oportunidade de aprender sobre as principais atualidades da profissão farmacêutica e o abrangente campo de atuação.
Prezado aluno, seja bem-vindo à disciplina de Atualidades em Farmácia I. Nela, você terá a oportunidade de aprender sobre as principais atualidades da profissão farmacêutica e o abrangente campo de atuação. Caro estudante, a inserção do profissional farmacêutico em equipes multiprofissionais envolvendo diferentes formações curriculares ou em atuações que necessitem de um conhecimento específico tem sido cada vez mais solicitada para atender a uma demanda mais exigente e atingir a qualidade desejada no atendimento do paciente.
Caro estudante, a inserção do profissional farmacêutico em equipes multiprofissionais envolvendo diferentes formações curriculares ou em atuações que necessitem de um conhecimento específico tem sido cada vez mais solicitada para atender a uma demanda mais exigente e atingir a qualidade desejada no atendimento do paciente. Prezado aluno, é com grande satisfação que iniciamos os estudos relacionados à disciplina Avaliação nutricional. Com certeza, você já deve ter se perguntado como avaliar corretamente um indivíduo ou uma população e sabe inferir a importância da avaliação nutricional em quaisquer populações, sejam elas saudáveis, doentes ou com objetivos específicos – a exemplo dos esportistas, gestantes, idosos, entre outras condições particulares.
Prezado aluno, é com grande satisfação que iniciamos os estudos relacionados à disciplina Avaliação nutricional. Com certeza, você já deve ter se perguntado como avaliar corretamente um indivíduo ou uma população e sabe inferir a importância da avaliação nutricional em quaisquer populações, sejam elas saudáveis, doentes ou com objetivos específicos – a exemplo dos esportistas, gestantes, idosos, entre outras condições particulares. Bem-vindo, aluno, à disciplina de Bacteriologia Clínica. Nela, você irá estudar as bactérias, sua constituição e estrutura. Irá entender como ocorre sua reprodução, fisiologia e seu metabolismo. A bacteriologia é uma ciência da área da Biologia. Está dentro da microbiologia, sendo uma subdivisão dela. A microbiologia estuda todos os seres microscópios em geral, enquanto a bacteriologia estuda especificamente as bactérias. Desse modo, iremos entender como as bactérias causam as doenças no organismo humano e a forma correta de tratamento.
Bem-vindo, aluno, à disciplina de Bacteriologia Clínica. Nela, você irá estudar as bactérias, sua constituição e estrutura. Irá entender como ocorre sua reprodução, fisiologia e seu metabolismo. A bacteriologia é uma ciência da área da Biologia. Está dentro da microbiologia, sendo uma subdivisão dela. A microbiologia estuda todos os seres microscópios em geral, enquanto a bacteriologia estuda especificamente as bactérias. Desse modo, iremos entender como as bactérias causam as doenças no organismo humano e a forma correta de tratamento. A alimentação é uma atividade inerente ao ser humano, pois encontramos nos alimentos componentes essenciais à vida. Atualmente, muito se fala a respeito de dietas, alimentos e a sua relação com a saúde e longevidade. Entretanto, boa parte da informação divulgada gera confusão e muita expectativa. Falar sobre o que comer e o que evitar comer é muito comum. Provavelmente, você, seus amigos ou pessoas muito próximas fazem comentários a respeito desse tema.
A alimentação é uma atividade inerente ao ser humano, pois encontramos nos alimentos componentes essenciais à vida. Atualmente, muito se fala a respeito de dietas, alimentos e a sua relação com a saúde e longevidade. Entretanto, boa parte da informação divulgada gera confusão e muita expectativa. Falar sobre o que comer e o que evitar comer é muito comum. Provavelmente, você, seus amigos ou pessoas muito próximas fazem comentários a respeito desse tema. Caros alunos, neste momento vamos iniciar o estudo da introdução à dietoterapia. Ao longo desta trajetória, iremos juntos entender como realizar a avaliação nutricional do paciente hospitalizado e como aplicar as diferentes dietas utilizadas no meio hospitalar. Você já parou para pensar em como é importante estudarmos os fatores que determinam o estado nutricional do indivíduo, assim como ofertarmos a dieta adequada de acordo com tipo de doença, condição física, nutricional, psicológica e social, mantendo ou recuperando o estado nutricional do indivíduo?
Caros alunos, neste momento vamos iniciar o estudo da introdução à dietoterapia. Ao longo desta trajetória, iremos juntos entender como realizar a avaliação nutricional do paciente hospitalizado e como aplicar as diferentes dietas utilizadas no meio hospitalar. Você já parou para pensar em como é importante estudarmos os fatores que determinam o estado nutricional do indivíduo, assim como ofertarmos a dieta adequada de acordo com tipo de doença, condição física, nutricional, psicológica e social, mantendo ou recuperando o estado nutricional do indivíduo? Caro aluno, apresentamos a você o livro didático que será utilizado na disciplina de Biologia Celular e Molecular, trazendo os principais conceitos e novas informações sobre a unidade de toda forma de vida: a célula. A biologia celular e molecular, também denominada citologia, é o ramo da ciência que estuda as células procariotas e eucariotas, seus mecanismos de controle e funcionamento, suas organelas e estruturas, entre outros detalhes do incrível mundo microscópico, que só foi possível de ser observado após muita evolução da ciência.
Caro aluno, apresentamos a você o livro didático que será utilizado na disciplina de Biologia Celular e Molecular, trazendo os principais conceitos e novas informações sobre a unidade de toda forma de vida: a célula. A biologia celular e molecular, também denominada citologia, é o ramo da ciência que estuda as células procariotas e eucariotas, seus mecanismos de controle e funcionamento, suas organelas e estruturas, entre outros detalhes do incrível mundo microscópico, que só foi possível de ser observado após muita evolução da ciência. Prezado aluno, a partir de agora você dará início ao estudo da Biologia Evolutiva e Molecular, que lhe fornecerá os conhecimentos necessários para compreender a história da evolução, suas causas e seus mecanismos, bem como as técnicas utilizadas para a análise e o entendimento desse processo. Você já reparou que cada espécie apresenta características próprias e parou para pensar na origem e no por quê dessas diferenças? O entendimento dos processos evolutivos e das técnicas de Biologia Molecular permitirá que você responda a questões sobre as hipóteses que podem explicar determinada característica dos organismos e os métodos pelos quais pesquisadores as testaram, aplicando os conhecimentos adquiridos em vivências relacionadas à sua formação.
Prezado aluno, a partir de agora você dará início ao estudo da Biologia Evolutiva e Molecular, que lhe fornecerá os conhecimentos necessários para compreender a história da evolução, suas causas e seus mecanismos, bem como as técnicas utilizadas para a análise e o entendimento desse processo. Você já reparou que cada espécie apresenta características próprias e parou para pensar na origem e no por quê dessas diferenças? O entendimento dos processos evolutivos e das técnicas de Biologia Molecular permitirá que você responda a questões sobre as hipóteses que podem explicar determinada característica dos organismos e os métodos pelos quais pesquisadores as testaram, aplicando os conhecimentos adquiridos em vivências relacionadas à sua formação. Escrever um livro dedicado à bioquímica oral requer um exercício de transferência do conhecimento básico para a prática clínica, muitas vezes de difícil assimilação e entendimento para o estudante logo nos primeiros meses em que ele inicia o curso de Odontologia. Neste livro, esse exercício foi feito de forma constante, entendendo que o papel da disciplina de Bioquímica no currículo desse curso é servir como base para que o futuro cirurgião-dentista entenda de forma mais completa os processos fisiológicos gerais que ocorrem com seu paciente, assim como compreenda a ocorrência de cárie e de doença periodontal, as mais prevalentes das doenças bucais.
Escrever um livro dedicado à bioquímica oral requer um exercício de transferência do conhecimento básico para a prática clínica, muitas vezes de difícil assimilação e entendimento para o estudante logo nos primeiros meses em que ele inicia o curso de Odontologia. Neste livro, esse exercício foi feito de forma constante, entendendo que o papel da disciplina de Bioquímica no currículo desse curso é servir como base para que o futuro cirurgião-dentista entenda de forma mais completa os processos fisiológicos gerais que ocorrem com seu paciente, assim como compreenda a ocorrência de cárie e de doença periodontal, as mais prevalentes das doenças bucais. Segundo a portaria 196 de 24 de junho de 1983 do ministério da saúde, infecção hospitalar é qualquer infecção adquirida após a internação do paciente e que se manifeste durante a internação ou até mesmo após a alta, quando puder ser relacionada com a hospitaliza-ção. No Brasil, a infecção hospitalar atinge hoje uma importância médico-social muito grande, pois calcu-la-se que seja a quarta causa de morte, perdendo para as cardiopatias, gastrenterites e neoplasias. A infecção hospitalar é no Brasil um ônus para a sociedade devido ao gigantismo dos hospitais, a sofisticação da medicina, ao processo no campo dos antibióticos, ao número ex-cessivo de leitos num só local, as salas de cirurgias não isoladas ao tráfego de doentes intensos profissionais e visitantes.
Segundo a portaria 196 de 24 de junho de 1983 do ministério da saúde, infecção hospitalar é qualquer infecção adquirida após a internação do paciente e que se manifeste durante a internação ou até mesmo após a alta, quando puder ser relacionada com a hospitaliza-ção. No Brasil, a infecção hospitalar atinge hoje uma importância médico-social muito grande, pois calcu-la-se que seja a quarta causa de morte, perdendo para as cardiopatias, gastrenterites e neoplasias. A infecção hospitalar é no Brasil um ônus para a sociedade devido ao gigantismo dos hospitais, a sofisticação da medicina, ao processo no campo dos antibióticos, ao número ex-cessivo de leitos num só local, as salas de cirurgias não isoladas ao tráfego de doentes intensos profissionais e visitantes. Prezado(a) aluno(a), vamos ingressar nesta nova proposta de estudo tendo a certeza de que, ao final deste livro a respeito da Bioética e Biossegurança, você adquirirá informações importantes que são fundamentais para o seu futuro profissional na profissão que você escolheu na área da saúde.
Prezado(a) aluno(a), vamos ingressar nesta nova proposta de estudo tendo a certeza de que, ao final deste livro a respeito da Bioética e Biossegurança, você adquirirá informações importantes que são fundamentais para o seu futuro profissional na profissão que você escolheu na área da saúde. Prezado aluno, seja bem-vindo aos estudos de Bioética e Legislação em Enfermagem! Explore ao máximo o conteúdo disponibilizado, pois os assuntos e temas abordados serão de relevância significativa no cotidiano de sua vida profissional. Pelos conceitos e discussões apresentados você compreenderá a importância da ética em sua profissão, que será fundamental para a carreira que escolheu seguir.
Prezado aluno, seja bem-vindo aos estudos de Bioética e Legislação em Enfermagem! Explore ao máximo o conteúdo disponibilizado, pois os assuntos e temas abordados serão de relevância significativa no cotidiano de sua vida profissional. Pelos conceitos e discussões apresentados você compreenderá a importância da ética em sua profissão, que será fundamental para a carreira que escolheu seguir. A química faz parte do ramo das Ciências da Natureza e estuda as propriedades dos elementos e das substâncias, sua composição, estrutura e a energia envolvida nesses processos.
A química faz parte do ramo das Ciências da Natureza e estuda as propriedades dos elementos e das substâncias, sua composição, estrutura e a energia envolvida nesses processos. Este livro foi escrito com a finalidade de ressaltar as bases histopatológicas indispensáveis para a tomada de decisões clínicas relativas ao diagnóstico e ao tratamento das lesões cariosas em humanos. Resultados de pesquisas realizadas em centros avançados foram incluídos juntamente com nossa experiência laboratorial e clínica. Todas as fotos são originais e ilustram, na sua maioria, observações e experimentos simples realizados em laboratórios dos departamentos de Morfologia e Ecologia e Sistemática da Universidade Federal da Paraíba.
Este livro foi escrito com a finalidade de ressaltar as bases histopatológicas indispensáveis para a tomada de decisões clínicas relativas ao diagnóstico e ao tratamento das lesões cariosas em humanos. Resultados de pesquisas realizadas em centros avançados foram incluídos juntamente com nossa experiência laboratorial e clínica. Todas as fotos são originais e ilustram, na sua maioria, observações e experimentos simples realizados em laboratórios dos departamentos de Morfologia e Ecologia e Sistemática da Universidade Federal da Paraíba. Por muitos anos, o tratamento da cárie baseou-se no tratamento de sua sequela-as cavidades de cárie. O diagnóstico da doença ocorria somente quando se observava, clinicamente, certo grau de destruição do dente, e esse diagnóstico tardio levava ao tratamento da sequela da doença - ou seja, ao tratamento restaurador-, sem, no entanto, se reconhecer a necessidade de controlar a doença em si.
Por muitos anos, o tratamento da cárie baseou-se no tratamento de sua sequela-as cavidades de cárie. O diagnóstico da doença ocorria somente quando se observava, clinicamente, certo grau de destruição do dente, e esse diagnóstico tardio levava ao tratamento da sequela da doença - ou seja, ao tratamento restaurador-, sem, no entanto, se reconhecer a necessidade de controlar a doença em si. Por muitos anos, o tratamento da carie baseou-se no tratamento de sua sequela-as cavidades de cărie. O diagnóstico da doença ocorria somente quando se observava, clinicamente, certo grau de destruição do dente, e esse diagnóstico tardio levava ao tratamento da sequela da doença - ou seja, ao tratamento restaurador-, sem, no entanto, se reconhecer a necessidade de controlar a doença em si.
Por muitos anos, o tratamento da carie baseou-se no tratamento de sua sequela-as cavidades de cărie. O diagnóstico da doença ocorria somente quando se observava, clinicamente, certo grau de destruição do dente, e esse diagnóstico tardio levava ao tratamento da sequela da doença - ou seja, ao tratamento restaurador-, sem, no entanto, se reconhecer a necessidade de controlar a doença em si. Em virtude da resposta positiva dos estudantes que utilizaram a 1a edição, ficamos satisfeitos quando os editores nos solicitaram a 2a edição. A abordagem de solução de problemas no formato de perguntas e respostas tem provado ser popular, assim como os Mind Maps. A filosofia do livro permanece a mesma da 1a edição. Nesta, o leitor é apresentado a um problema clínico e então levado a passos sequenciais lógicos de avaliação de casos, diagnóstico e planejamento do tratamento. Todos os capítulos foram atualizados.
Em virtude da resposta positiva dos estudantes que utilizaram a 1a edição, ficamos satisfeitos quando os editores nos solicitaram a 2a edição. A abordagem de solução de problemas no formato de perguntas e respostas tem provado ser popular, assim como os Mind Maps. A filosofia do livro permanece a mesma da 1a edição. Nesta, o leitor é apresentado a um problema clínico e então levado a passos sequenciais lógicos de avaliação de casos, diagnóstico e planejamento do tratamento. Todos os capítulos foram atualizados. O conceito de estética é amplo. Pode ser filosoficamente entendido como “estudo racional do belo, quer quanto à possibilidade de sua conceituação, quer quanto à diversidade de emoções que ela suscita no homem".49 Etcoff47 em seu livro A lei do mais belo chega a defender a tese de que, em competições, tão necessárias para a evolução do ser humano, a beleza é um fator decisivo, quando o mais feio é comumente preterido e o mais bonito, o preferido.
O conceito de estética é amplo. Pode ser filosoficamente entendido como “estudo racional do belo, quer quanto à possibilidade de sua conceituação, quer quanto à diversidade de emoções que ela suscita no homem".49 Etcoff47 em seu livro A lei do mais belo chega a defender a tese de que, em competições, tão necessárias para a evolução do ser humano, a beleza é um fator decisivo, quando o mais feio é comumente preterido e o mais bonito, o preferido. Como nas edições anteriores deste texto altamente conceituado, a sexta edição de Cirurgia Oral e Maxilofacial Contemporânea pretende apresentar os princípios fundamentais de conduta médica e cirúrgica dos problemas de cirurgia oral. Esta obra oferece detalhes adequados sobre técnicas fundamentais de avaliação, diagnóstico e conduta médica, o que torna possível a aplicação clínica imediata. A grande quantidade de ilustrações tem o objetivo de tornar as técnicas cirúrgicas facilmente compreensíveis, enquanto reforça também a compreensão dos leitores para os aspectos técnicos e biológicos, de modo que possam ser capazes de reagir as situações cirúrgicas vão além dos "casos clínicos contidos em manuais"
Como nas edições anteriores deste texto altamente conceituado, a sexta edição de Cirurgia Oral e Maxilofacial Contemporânea pretende apresentar os princípios fundamentais de conduta médica e cirúrgica dos problemas de cirurgia oral. Esta obra oferece detalhes adequados sobre técnicas fundamentais de avaliação, diagnóstico e conduta médica, o que torna possível a aplicação clínica imediata. A grande quantidade de ilustrações tem o objetivo de tornar as técnicas cirúrgicas facilmente compreensíveis, enquanto reforça também a compreensão dos leitores para os aspectos técnicos e biológicos, de modo que possam ser capazes de reagir as situações cirúrgicas vão além dos "casos clínicos contidos em manuais" Seja bem-vindo à nossa disciplina de Ciências Morfofuncionais do Aparelho Locomotor – Membros Inferiores e Coluna Vertebral. Esta disciplina, pela sua denominação, já justifica sua importância na formação de profissionais da área da saúde, principalmente daqueles que atuarão com o sistema musculoesquelético, seja na avaliação ou no tratamento, pois um bom profissional só conseguirá desenvolver adequadamente as suas atividades quando ele detiver amplo conhecimento sobre como o corpo funciona normalmente. Por isso enfatizo a necessidade de dar atenção especial e estabelecer uma rotina de estudos para que esse conteúdo denso seja assimilado adequadamente.
Seja bem-vindo à nossa disciplina de Ciências Morfofuncionais do Aparelho Locomotor – Membros Inferiores e Coluna Vertebral. Esta disciplina, pela sua denominação, já justifica sua importância na formação de profissionais da área da saúde, principalmente daqueles que atuarão com o sistema musculoesquelético, seja na avaliação ou no tratamento, pois um bom profissional só conseguirá desenvolver adequadamente as suas atividades quando ele detiver amplo conhecimento sobre como o corpo funciona normalmente. Por isso enfatizo a necessidade de dar atenção especial e estabelecer uma rotina de estudos para que esse conteúdo denso seja assimilado adequadamente. Prezado aluno do curso de Fisioterapia, seja bem-vindo à disciplina de Ciências Morfofuncionais do Aparelho Locomotor - Membros Superiores, Cabeça e Tronco. Essa disciplina é muito importante para o seu aprendizado e formação profissional. Na Unidade 1 você vai aprender sobre o estudo morfofuncional do complexo do ombro e lá vamos ver os princípios biomecânicos e a classificação de todos os componentes das articulações do ombro, entre elas a articulação glenoumeral e as ações musculares. Já na Unidade 2 vamos abordar o estudo morfofuncional do cotovelo e do antebraço. Nesta parte falaremos sobre a classificação e componentes, ação muscular e processos biomecânicos. Na Unidade 3 veremos o estudo morfofuncional do punho e mão, seus componentes e classificação, o processo muscular e todas as ações biomecânicas dos movimentos. E, para finalizar, na Unidade 4 explanaremos o estudo morfofuncional da articulação temporomandibular e da caixa torácica, ação biomecânica da mastigação, além dos componentes e processos biomecânicos da respiração.
Prezado aluno do curso de Fisioterapia, seja bem-vindo à disciplina de Ciências Morfofuncionais do Aparelho Locomotor - Membros Superiores, Cabeça e Tronco. Essa disciplina é muito importante para o seu aprendizado e formação profissional. Na Unidade 1 você vai aprender sobre o estudo morfofuncional do complexo do ombro e lá vamos ver os princípios biomecânicos e a classificação de todos os componentes das articulações do ombro, entre elas a articulação glenoumeral e as ações musculares. Já na Unidade 2 vamos abordar o estudo morfofuncional do cotovelo e do antebraço. Nesta parte falaremos sobre a classificação e componentes, ação muscular e processos biomecânicos. Na Unidade 3 veremos o estudo morfofuncional do punho e mão, seus componentes e classificação, o processo muscular e todas as ações biomecânicas dos movimentos. E, para finalizar, na Unidade 4 explanaremos o estudo morfofuncional da articulação temporomandibular e da caixa torácica, ação biomecânica da mastigação, além dos componentes e processos biomecânicos da respiração. Olá, caro aluno! Seja bem-vindo aos estudos do incrível “mundo” das Ciências Morfofuncionais dos sistemas imune e hematológico! Esta área da ciência da saúde estuda os organismos vivos desde suas reações intracelulares moleculares até sua formação sistêmica. Você consegue imaginar essas reações acontecendo no interior das células e levando-as a uma transformação como se fosse uma “metamorfose”?
Olá, caro aluno! Seja bem-vindo aos estudos do incrível “mundo” das Ciências Morfofuncionais dos sistemas imune e hematológico! Esta área da ciência da saúde estuda os organismos vivos desde suas reações intracelulares moleculares até sua formação sistêmica. Você consegue imaginar essas reações acontecendo no interior das células e levando-as a uma transformação como se fosse uma “metamorfose”? Caro aluno, vamos aprender nesta aula conceitos sobre o sistema urinário e suas funções, associando-as à realidade do aluno. Certamente, você está preparado para iniciar os estudos da disciplina, garantindo a aquisição de informações fundamentais para a sua vida profissional. Em nossa rotina diária, podemos nos deparar com situações que vamos trabalhar ao longo deste livro, utilizando sem perceber os conceitos apresentados, facilitando o aprendizado. Dessa forma vamos iniciar o estudo dos diferentes sistemas abordados nesta unidade de ensino, explicando as funções vitais do organismo.
Caro aluno, vamos aprender nesta aula conceitos sobre o sistema urinário e suas funções, associando-as à realidade do aluno. Certamente, você está preparado para iniciar os estudos da disciplina, garantindo a aquisição de informações fundamentais para a sua vida profissional. Em nossa rotina diária, podemos nos deparar com situações que vamos trabalhar ao longo deste livro, utilizando sem perceber os conceitos apresentados, facilitando o aprendizado. Dessa forma vamos iniciar o estudo dos diferentes sistemas abordados nesta unidade de ensino, explicando as funções vitais do organismo. Vamos começar o estudo sobre o sistema nervoso e cardiorrespiratório associado ao dia a dia. Certeza que você está preparado para ingressar nesta nova proposta de estudo e que, ao final deste livro, será proporcionada a você uma quantidade imensa de informações que serão fundamentais para a sua vida profissional no futuro.
Vamos começar o estudo sobre o sistema nervoso e cardiorrespiratório associado ao dia a dia. Certeza que você está preparado para ingressar nesta nova proposta de estudo e que, ao final deste livro, será proporcionada a você uma quantidade imensa de informações que serão fundamentais para a sua vida profissional no futuro. Olá, aluno, seja bem-vindo! Você está sendo convidado a desmontar e remontar a incrível máquina de sustentação e movimento da vida: Os sistemas Tegumentar e Esquelético do Corpo Humano. Iniciaremos nosso estudo pelo entendimento do que são esses sistemas, qual sua composição, origem e como ocorre o seu funcionamento. Você consegue imaginar como seriam os seres vivos, dentre eles nós, seres humanos, sem nossa pele e nosso esqueleto?
Olá, aluno, seja bem-vindo! Você está sendo convidado a desmontar e remontar a incrível máquina de sustentação e movimento da vida: Os sistemas Tegumentar e Esquelético do Corpo Humano. Iniciaremos nosso estudo pelo entendimento do que são esses sistemas, qual sua composição, origem e como ocorre o seu funcionamento. Você consegue imaginar como seriam os seres vivos, dentre eles nós, seres humanos, sem nossa pele e nosso esqueleto? A disciplina de Clínica Integrada da Faculdade de Odontologia da Universidade de São Paulo (FOUSP), antigamente denominada policlínica, vem desde 1973 sendo reorganizada, para que possa efetivamente refletir sua lmport.ancia no currículo odontológico.
A disciplina de Clínica Integrada da Faculdade de Odontologia da Universidade de São Paulo (FOUSP), antigamente denominada policlínica, vem desde 1973 sendo reorganizada, para que possa efetivamente refletir sua lmport.ancia no currículo odontológico. Queimaduras vêm sendo um grande problema não só quanto à gravidade de suas lesões agudas como em relação às importantes seqüelas que marcarão para sempre o paciente queimado.
Queimaduras vêm sendo um grande problema não só quanto à gravidade de suas lesões agudas como em relação às importantes seqüelas que marcarão para sempre o paciente queimado. Este manual, em sua sétima edição, é a ajuda mais prática que você pode encontrar para a tarefa de efetuar ou conferir cálculos de doses de medicamentos. As qualidades do texto, entretanto, não se resumem a isso. Além de ser objetivo, portátil e de fácil acesso, o livro é abrangente como nenhum outro – ao ponto de conter uma conveniente revisão da matemática básica.
Este manual, em sua sétima edição, é a ajuda mais prática que você pode encontrar para a tarefa de efetuar ou conferir cálculos de doses de medicamentos. As qualidades do texto, entretanto, não se resumem a isso. Além de ser objetivo, portátil e de fácil acesso, o livro é abrangente como nenhum outro – ao ponto de conter uma conveniente revisão da matemática básica. O estudo sobre os aspectos microscópicos da cárie dentária permite correlacionar as alterações observadas com os mecanismos patogénicos para um entendimento dinâmico sobre o assunto.
O estudo sobre os aspectos microscópicos da cárie dentária permite correlacionar as alterações observadas com os mecanismos patogénicos para um entendimento dinâmico sobre o assunto. O termo cárie dentária é usado para descrever os resultados - sinais e sintomas - de uma dissolução química da estrutura dentária causada pelos eventos metabólicos ocorrendo no biofilme (placa dentária) que cobre área afetada. A destruição pode afetar esmalte, dentina e cemento. As lesões podem se manifestar clinicamente de diversas formas, como serão mostradas no próximo capítulo.
O termo cárie dentária é usado para descrever os resultados - sinais e sintomas - de uma dissolução química da estrutura dentária causada pelos eventos metabólicos ocorrendo no biofilme (placa dentária) que cobre área afetada. A destruição pode afetar esmalte, dentina e cemento. As lesões podem se manifestar clinicamente de diversas formas, como serão mostradas no próximo capítulo. Ao ingressar nesta nova proposta de estudo esperamos, que ao final deste livro didático, você tenha uma grande quantidade de informações importantes que serão fundamentais para o seu futuro como profissional fisioterapeuta, membro de uma das profissões da área da saúde que você escolheu. Neste livro você terá acesso a todas as informações relacionadas ao Diagnóstico Cinético-Funcional e Imaginologia de Membros Inferiores e Coluna Vertebral, por meio da divisão dos vários assuntos em unidades que são:
Ao ingressar nesta nova proposta de estudo esperamos, que ao final deste livro didático, você tenha uma grande quantidade de informações importantes que serão fundamentais para o seu futuro como profissional fisioterapeuta, membro de uma das profissões da área da saúde que você escolheu. Neste livro você terá acesso a todas as informações relacionadas ao Diagnóstico Cinético-Funcional e Imaginologia de Membros Inferiores e Coluna Vertebral, por meio da divisão dos vários assuntos em unidades que são: A edição de Diagnósticos de enfermagem da NANDA: definições e classificação 2007-2008 traz a maior quantidade de revisões e acréscimos de diagnósticos de enfermagem à taxonomia da NANDA Internacional em muitos anos. E com prazer que anunciamos o acréscimo de 15 novos diagnósticos, bem como 26 diagnósticos revisados. Os novos diagnósticos refletem uma ênfase na promoção da saúde e incluem dois diagnósticos com foco na comunidade: Contaminação e Risco de Contaminação. Quatro das revisões aceitas foram enviadas por pessoas de fora dos Estados Unidos (Brasil e Canadá), o que reflete a crescente internacionalização da terminologia dos diagnósticos de enfermagem. O Conselho de Diretores continua a encorajar a participação de todos os países, a fim de possibilitar a contínua utilização e aplicabilidade global da terminologia dos diagnósticos de enfermagem.
A edição de Diagnósticos de enfermagem da NANDA: definições e classificação 2007-2008 traz a maior quantidade de revisões e acréscimos de diagnósticos de enfermagem à taxonomia da NANDA Internacional em muitos anos. E com prazer que anunciamos o acréscimo de 15 novos diagnósticos, bem como 26 diagnósticos revisados. Os novos diagnósticos refletem uma ênfase na promoção da saúde e incluem dois diagnósticos com foco na comunidade: Contaminação e Risco de Contaminação. Quatro das revisões aceitas foram enviadas por pessoas de fora dos Estados Unidos (Brasil e Canadá), o que reflete a crescente internacionalização da terminologia dos diagnósticos de enfermagem. O Conselho de Diretores continua a encorajar a participação de todos os países, a fim de possibilitar a contínua utilização e aplicabilidade global da terminologia dos diagnósticos de enfermagem. Esta obra visa apresentar sob os pontos de vita prático, clinico e contifico, os principais aspectos do procodimento da disjunção maxilar, tanto sob o enfoque ortodontico ortopédico como a cirúrgico. Abordamos também a integraçla da Odontologia com a Mendcana e a Fenonadiologia. Um dos aspectos que procuramos demonstrar são os diversos modos de tratamento da correção da atresia manilar, sua percusão na qualidade de vida e as vertaples dos diversos tipos de aparelhos para a disjunção maxılar.
Esta obra visa apresentar sob os pontos de vita prático, clinico e contifico, os principais aspectos do procodimento da disjunção maxilar, tanto sob o enfoque ortodontico ortopédico como a cirúrgico. Abordamos também a integraçla da Odontologia com a Mendcana e a Fenonadiologia. Um dos aspectos que procuramos demonstrar são os diversos modos de tratamento da correção da atresia manilar, sua percusão na qualidade de vida e as vertaples dos diversos tipos de aparelhos para a disjunção maxılar. A proposta deste livro é envolver saúde e educação em ações de diagnose preventiva e curativa para a respiração oral e suas possiveis comorbidades imediatas ou tardias, especialmente aquelas que cursam com os distúrbios respiratórios obstrutivos do sono. Vale salientar a alta prevalência da respiração oral e das doenças respiratórias relacionadas ao sono na infância. As crianças acometidas podem apresentar retardo do crescimento ponderoestatural, distúrbios respiratórios com frequência maior de apneia obstrutiva, alterações cardiológicas como a hipertensão arterial sistémica, cefaleia, dis- túrbios neuropsiquicos como as alterações do comportamento, hiperatividade, sono não restaurador. irritabilidade, difi- culdade de concentração e redução no desempenho escolar.
A proposta deste livro é envolver saúde e educação em ações de diagnose preventiva e curativa para a respiração oral e suas possiveis comorbidades imediatas ou tardias, especialmente aquelas que cursam com os distúrbios respiratórios obstrutivos do sono. Vale salientar a alta prevalência da respiração oral e das doenças respiratórias relacionadas ao sono na infância. As crianças acometidas podem apresentar retardo do crescimento ponderoestatural, distúrbios respiratórios com frequência maior de apneia obstrutiva, alterações cardiológicas como a hipertensão arterial sistémica, cefaleia, dis- túrbios neuropsiquicos como as alterações do comportamento, hiperatividade, sono não restaurador. irritabilidade, difi- culdade de concentração e redução no desempenho escolar. É com grande satisfação que o Centro Nacional de Epidemiologia - CENEPI demandou a revisão e ampliação da 2a. edição do Guia de Bolso de Doenças Infecciosas e Parasitárias. Essa revisão obedeceu os mesmos critérios para arrastarias elaboração da 1a. edição, ou seja, observou todos os manuais e/ou normas técnicas daquelas doenças que são objeto de intervenção do Ministério da Saúde-MS, conta portanto com a participação de vários técnicos do MS, e especialistas na área. O lançamento dessa 2a. edição, também especialmente dirigido para os médicos que necessitam obter, em sua prática do dia a dia, informações atualizadas sobre aspectos clínicos, epidemiológicos e medidas de prevenção e controle das doenças que se encontram sob monitoramento devido a sua potencialidade em causar dano à saúde pública.
É com grande satisfação que o Centro Nacional de Epidemiologia - CENEPI demandou a revisão e ampliação da 2a. edição do Guia de Bolso de Doenças Infecciosas e Parasitárias. Essa revisão obedeceu os mesmos critérios para arrastarias elaboração da 1a. edição, ou seja, observou todos os manuais e/ou normas técnicas daquelas doenças que são objeto de intervenção do Ministério da Saúde-MS, conta portanto com a participação de vários técnicos do MS, e especialistas na área. O lançamento dessa 2a. edição, também especialmente dirigido para os médicos que necessitam obter, em sua prática do dia a dia, informações atualizadas sobre aspectos clínicos, epidemiológicos e medidas de prevenção e controle das doenças que se encontram sob monitoramento devido a sua potencialidade em causar dano à saúde pública. Desde sua introdução no início do século passado por Willem Einthoven, o eletrocardiograma
Desde sua introdução no início do século passado por Willem Einthoven, o eletrocardiograma Este livro é dedicado aos estudantes de Medicina e da área da saúde que desejam ser inseridos no universo que envolve o estudo e a compreensão do eletrocardiograma (ECG).
Este livro é dedicado aos estudantes de Medicina e da área da saúde que desejam ser inseridos no universo que envolve o estudo e a compreensão do eletrocardiograma (ECG). O perfil epidemiológico das emergências psiquiátricas vem mudando significativamente nas últimas duas décadas em virtude da reforma psiquiátrica. Por conseguinte, elas, hoje, são inicialmente atendidas mais amiúde em serviços de emergência dos hospitais gerais. As emergências psiquiátricas são um problema de saúde pública e se apresentam de diversas formas, sendo, portanto, um tema relevante para médicos e profissionais da saúde de modo geral. O estigma, as concepções errôneas e a falta de treinamento são fontes de insegurança para muitos profissionais da saúde que se deparam com pacientes agitados e/ou agressivos. Além do manejo técnico, as emergências psiquiátricas estão associadas a potenciais desdobramentos de cunho ético e legal, notavelmente os internamentos involuntários. Trata-se, pois, de tema complexo e abrangente. Na presente edição, buscamos prover ao leitor uma referência ao mesmo tempo sucinta e abrangente, que permita simultaneamente o estudo e a rápida consulta no contexto das emergências psiquiátricas. Sempre que possível, a obra foi enriquecida com algoritmos e fluxogramas que viabilizam a aplicação dos conceitos e ferramentas terapêuticas abordados. Esperamos que este livro contribua para o melhor manejo possível das emergências psiquiátricas.
O perfil epidemiológico das emergências psiquiátricas vem mudando significativamente nas últimas duas décadas em virtude da reforma psiquiátrica. Por conseguinte, elas, hoje, são inicialmente atendidas mais amiúde em serviços de emergência dos hospitais gerais. As emergências psiquiátricas são um problema de saúde pública e se apresentam de diversas formas, sendo, portanto, um tema relevante para médicos e profissionais da saúde de modo geral. O estigma, as concepções errôneas e a falta de treinamento são fontes de insegurança para muitos profissionais da saúde que se deparam com pacientes agitados e/ou agressivos. Além do manejo técnico, as emergências psiquiátricas estão associadas a potenciais desdobramentos de cunho ético e legal, notavelmente os internamentos involuntários. Trata-se, pois, de tema complexo e abrangente. Na presente edição, buscamos prover ao leitor uma referência ao mesmo tempo sucinta e abrangente, que permita simultaneamente o estudo e a rápida consulta no contexto das emergências psiquiátricas. Sempre que possível, a obra foi enriquecida com algoritmos e fluxogramas que viabilizam a aplicação dos conceitos e ferramentas terapêuticas abordados. Esperamos que este livro contribua para o melhor manejo possível das emergências psiquiátricas. Esta obra apresenta uma visão completa e atualizada da Enfermagem Clínica Cirúrgica, abordando desde os fundamentos do cuidado pré, trans e pós-operatório até a atuação do enfermeiro em diferentes especialidades cirúrgicas. Com base em protocolos atualizados, evidências científicas e práticas seguras, o livro oferece subsídios essenciais para a tomada de decisão clínica, planejamento da assistência e promoção da recuperação do paciente cirúrgico. Destinado a estudantes, docentes e profissionais da enfermagem, este material contribui para o aprimoramento da prática assistencial, valorizando o cuidado humanizado, a segurança do paciente e a ética profissional no ambiente hospitalar.
Esta obra apresenta uma visão completa e atualizada da Enfermagem Clínica Cirúrgica, abordando desde os fundamentos do cuidado pré, trans e pós-operatório até a atuação do enfermeiro em diferentes especialidades cirúrgicas. Com base em protocolos atualizados, evidências científicas e práticas seguras, o livro oferece subsídios essenciais para a tomada de decisão clínica, planejamento da assistência e promoção da recuperação do paciente cirúrgico. Destinado a estudantes, docentes e profissionais da enfermagem, este material contribui para o aprimoramento da prática assistencial, valorizando o cuidado humanizado, a segurança do paciente e a ética profissional no ambiente hospitalar. Nesta apostila abordaremos o funcionamento dos diversos sistemas que compõem o nosso organismo e as alterações
Nesta apostila abordaremos o funcionamento dos diversos sistemas que compõem o nosso organismo e as alterações O interesse da sociedade pelas crianças nem sempre esteve presente. Até o Século XVII, a criança era vista como estorvo, desgraça, um fardo insuportável para a família. Os cuidados dispensados ao bebê não eram uma tarefa agradável aos pais. O índice de mortalidade infantil era elevado, especialmente entre crianças que eram afastadas de seus pais e cuidadas por amas de leite. Outras causas de mortalidade eram a precariedade das condições de higiene e a ausência de especialidade
O interesse da sociedade pelas crianças nem sempre esteve presente. Até o Século XVII, a criança era vista como estorvo, desgraça, um fardo insuportável para a família. Os cuidados dispensados ao bebê não eram uma tarefa agradável aos pais. O índice de mortalidade infantil era elevado, especialmente entre crianças que eram afastadas de seus pais e cuidadas por amas de leite. Outras causas de mortalidade eram a precariedade das condições de higiene e a ausência de especialidade Todo livro tem em seu interior uma energia própria, que permite uma liberdade de reflexão. Endodontia laboratorial e clínica dá continuidade a um trabalho científico e técnico acerca dos procedimentos operatórios envolvidos no tratamento dos canais radiculares. Todas as particularidades necessárias ao moderno conceito e a operacionalização dos procedimentos endodônticos foram aqui cuidadosamente elaboradas, utilizando estratégias que facilitam o aprendizado.
Todo livro tem em seu interior uma energia própria, que permite uma liberdade de reflexão. Endodontia laboratorial e clínica dá continuidade a um trabalho científico e técnico acerca dos procedimentos operatórios envolvidos no tratamento dos canais radiculares. Todas as particularidades necessárias ao moderno conceito e a operacionalização dos procedimentos endodônticos foram aqui cuidadosamente elaboradas, utilizando estratégias que facilitam o aprendizado. Este livro aborda de forma abrangente e humanizada os principais aspectos da Enfermagem Materno Infantil, oferecendo suporte teórico e prático para estudantes, profissionais de enfermagem e demais atuantes na área da saúde. Com foco no cuidado integral à mulher, ao recém-nascido e à criança, a obra contempla temas como o pré-natal, parto, puerpério, aleitamento materno, crescimento e desenvolvimento infantil, além de aspectos éticos e legais do exercício profissional. Fundamentado em evidências científicas e nas diretrizes do cuidado humanizado, este material visa qualificar a assistência, promovendo saúde, acolhimento e segurança em todas as fases do ciclo gravídico-puerperal e na primeira infância.
Este livro aborda de forma abrangente e humanizada os principais aspectos da Enfermagem Materno Infantil, oferecendo suporte teórico e prático para estudantes, profissionais de enfermagem e demais atuantes na área da saúde. Com foco no cuidado integral à mulher, ao recém-nascido e à criança, a obra contempla temas como o pré-natal, parto, puerpério, aleitamento materno, crescimento e desenvolvimento infantil, além de aspectos éticos e legais do exercício profissional. Fundamentado em evidências científicas e nas diretrizes do cuidado humanizado, este material visa qualificar a assistência, promovendo saúde, acolhimento e segurança em todas as fases do ciclo gravídico-puerperal e na primeira infância. Prezado aluno! Seja bem-vindo aos estudos de Enfermagem em Centro Cirúrgico! Aproveite o conteúdo que será disponibilizado, pesquise e estude, pois os assuntos abordados serão significativos: para sua vida profissional. Por meio dos conceitos e discussões apresentados você compreenderá o papel do enfermeiro em Centro Cirúrgico e Central de Material e Esterilização também entenderá a importância da organização e gestão dessas Unidades para a dinâmica da assistência ao paciente em outras unidades do ambiente hospitalar, do paciente
Prezado aluno! Seja bem-vindo aos estudos de Enfermagem em Centro Cirúrgico! Aproveite o conteúdo que será disponibilizado, pesquise e estude, pois os assuntos abordados serão significativos: para sua vida profissional. Por meio dos conceitos e discussões apresentados você compreenderá o papel do enfermeiro em Centro Cirúrgico e Central de Material e Esterilização também entenderá a importância da organização e gestão dessas Unidades para a dinâmica da assistência ao paciente em outras unidades do ambiente hospitalar, do paciente Futuro profissional de enfermagem, bem-vindo à disciplina Enfermagem na Saúde da Criança e do Adolescente. Você já deve ter ouvido alguém dizer: “Criança é um adulto pequeno!” Será? Nesta disciplina, descobriremos juntos o universo da saúde da criança e já adiantamos que ele nada tem a ver com o do adulto, por isso existe a especialidade pediatria. Vamos estratificar as especialidades dentro da pediatria, como a neonatologia e a herbiatria (adolescentes), mas de onde surgiu a ideia de que criança é um adulto pequeno? Vamos recorrer um pouco à História.
Futuro profissional de enfermagem, bem-vindo à disciplina Enfermagem na Saúde da Criança e do Adolescente. Você já deve ter ouvido alguém dizer: “Criança é um adulto pequeno!” Será? Nesta disciplina, descobriremos juntos o universo da saúde da criança e já adiantamos que ele nada tem a ver com o do adulto, por isso existe a especialidade pediatria. Vamos estratificar as especialidades dentro da pediatria, como a neonatologia e a herbiatria (adolescentes), mas de onde surgiu a ideia de que criança é um adulto pequeno? Vamos recorrer um pouco à História. Prezado aluno! Seja muito bem-vindo à disciplina de Enfermagem na Saúde da Mulher, uma disciplina mais específica da sua área de formação. Até agora você adquiriu muitos conhecimentos importantes na construção de seu aprendizado por meio das disciplinas já cursadas. Neste momento, você adquirirá conhecimentos voltados para os cuidados da saúde da mulher, tanto na área da ginecologia quanto na obstetrícia, visando garantir uma assistência de qualidade aos pacientes. É importante que você se organize para estudar de maneira disciplinada e ter contato com todo o material disponível antes do encontro com seu professor. Crie uma rotina e anote todas as suas dúvidas para que sejam sanadas no momento propício.
Prezado aluno! Seja muito bem-vindo à disciplina de Enfermagem na Saúde da Mulher, uma disciplina mais específica da sua área de formação. Até agora você adquiriu muitos conhecimentos importantes na construção de seu aprendizado por meio das disciplinas já cursadas. Neste momento, você adquirirá conhecimentos voltados para os cuidados da saúde da mulher, tanto na área da ginecologia quanto na obstetrícia, visando garantir uma assistência de qualidade aos pacientes. É importante que você se organize para estudar de maneira disciplinada e ter contato com todo o material disponível antes do encontro com seu professor. Crie uma rotina e anote todas as suas dúvidas para que sejam sanadas no momento propício. Prezado aluno! Neste momento você está ingressando na disciplina Enfermagem na Saúde do Adulto e deve estar imaginando qual a relevância dessa disciplina para seu futuro como enfermeiro. Esta é uma área de grande importância em sua carreira profissional, por meio dela você irá relacionar as disciplinas básicas da área de enfermagem às especialidades, como a saúde do adulto, combinando a teoria com a prática e o uso do raciocínio clínico e crítico para tomadas de decisões. O enfermeiro profissional deve ter o conhecimento técnico-científico para garantir a qualidade de assistência nas áreas de promoção da saúde, prevenção e tratamento doenças e reabilitação dos indivíduos.
Prezado aluno! Neste momento você está ingressando na disciplina Enfermagem na Saúde do Adulto e deve estar imaginando qual a relevância dessa disciplina para seu futuro como enfermeiro. Esta é uma área de grande importância em sua carreira profissional, por meio dela você irá relacionar as disciplinas básicas da área de enfermagem às especialidades, como a saúde do adulto, combinando a teoria com a prática e o uso do raciocínio clínico e crítico para tomadas de decisões. O enfermeiro profissional deve ter o conhecimento técnico-científico para garantir a qualidade de assistência nas áreas de promoção da saúde, prevenção e tratamento doenças e reabilitação dos indivíduos. Neste momento, você está ingressando na disciplina de Enfermagem na Saúde do Idoso. Imaginamos que deva estar se questionando qual a importância/relevância dessa disciplina para seu futuro como enfermeiro. Esta disciplina tem uma grande importância em sua carreira profissional, pois proporcionará uma correlação entre as disciplinas básicas da área de enfermagem com as especificidades do idoso, dessa forma, fará correlações entre as técnicas básicas gerais com a saúde da pessoa idosa e desenvolverá um raciocínio clínico e crítico para a tomada de decisão.
Neste momento, você está ingressando na disciplina de Enfermagem na Saúde do Idoso. Imaginamos que deva estar se questionando qual a importância/relevância dessa disciplina para seu futuro como enfermeiro. Esta disciplina tem uma grande importância em sua carreira profissional, pois proporcionará uma correlação entre as disciplinas básicas da área de enfermagem com as especificidades do idoso, dessa forma, fará correlações entre as técnicas básicas gerais com a saúde da pessoa idosa e desenvolverá um raciocínio clínico e crítico para a tomada de decisão. Caro aluno, o estudo de epidemiologia nutricional aborda os conceitos e aplicação
Caro aluno, o estudo de epidemiologia nutricional aborda os conceitos e aplicação A prática diuturna da odontologia é fortemente estafante. O estresse advém de fatores relacionados ao exercício profissional, tais como as características inadequadas do ambiente físico de trabalho nos quesitos iluminação, temperatura, ruído e cor, das exigências físicas da função - longas horas de trabalho, isolamento do cirurgião-dentista/equipe, trabalhos semirrepetitivos, competição entre profissionais e consequente necessidade de constante atualização e aperfeiçoamento técnico; do relacionamento profissional-paciente - lidar com suas expectativas, ansiedades, dores, faltas, atrasos, cancelamentos, falta de colaboração e não observância de instruções, inadimplência, entre outros e, por fim, a possibilidade de contágio por moléstias veiculadas pela saliva e sangue em função do inevitável contato fisico com o paciente durante todo o tratamento.
A prática diuturna da odontologia é fortemente estafante. O estresse advém de fatores relacionados ao exercício profissional, tais como as características inadequadas do ambiente físico de trabalho nos quesitos iluminação, temperatura, ruído e cor, das exigências físicas da função - longas horas de trabalho, isolamento do cirurgião-dentista/equipe, trabalhos semirrepetitivos, competição entre profissionais e consequente necessidade de constante atualização e aperfeiçoamento técnico; do relacionamento profissional-paciente - lidar com suas expectativas, ansiedades, dores, faltas, atrasos, cancelamentos, falta de colaboração e não observância de instruções, inadimplência, entre outros e, por fim, a possibilidade de contágio por moléstias veiculadas pela saliva e sangue em função do inevitável contato fisico com o paciente durante todo o tratamento.
 Farmacologia é a ciência que se ocupa do estudo das interações que acontecem entre um organismo vivo e drogas que afetam seu funcionamento, normal ou anormal.
Farmacologia é a ciência que se ocupa do estudo das interações que acontecem entre um organismo vivo e drogas que afetam seu funcionamento, normal ou anormal.